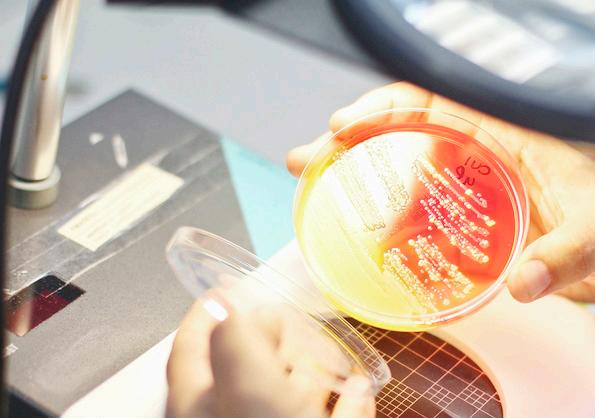

En estas fechas de estar en familia, los migrantes no lo están, se mantienen lejos de casa, con el único propósito de lograr el sueño americano, pero las condiciones para ellos no siempre son las optimas, ni favorables.Y precisamente se prepara una caravana para salir rumbo al norte, en plan de urgente. Estos migrantes que se encuentran en el sur de México se organizan para salir en caravanas desesperados y con el objetivo de poder llegar antes del 21 de diciembre a los Estados Unidos, cuando se pone fin al “Título 42”, política que expulsa a migrantes que intenten ingresar de manera ilegal a ese país. Este es el caso de una caravana de migrantes varados en Tapachula, en el sureño estado mexicano de Chiapas, que decidió organizarse este domingo y partir desde la frontera sur y hasta la frontera norte mexicana. Esto, con el único propósito de avanzar a los Estados Unidos, para poder mejorar su situación económica y poder darles un futuro mejor a sus familias. El grupo de migrantes de diversas nacionalidades realizó oraciones, pues caminarán en la única vía de acceso que comunica a la capital mexicana, donde circulan cientos de vehículos de carga pesada, transporte y particulares. El título 42 es una política estadounidense que permite a las autoridades estadounidenses denegar la entrada de personas o bienes en Estados Unidos, a fin de “evitar la propagación de enfermedades transmisibles”, sobre todo si es de forma irregular, y concluye el próximo 21 de diciembre. En esta nueva caravana de personas viajan, en su mayoría, mujeres con niños, hombres solos originarios de Ecuador, Venezuela, Colombia y Centroamérica.

La migrante de El Ecuador, Amparo Fernández, destacó que algunos llevan documentos que obtuvieron en Tapachula, mientras que otros van sin papeles caminando. Los migrantes como bien lo marcan van en desesperados de poder llegar, ya que muchos de ellos van en familia, llevan a sus hijos que son pequeños y lo que les preocupa es el plazo que tienen, que si no lo logran estarían fracasando en el intento y podría ahí terminar el sueño americano. De Venezuela, Keyson Castillo, quien se sumó este grupo de personas, señaló que viaja gente que viene huyendo de los países en crisis como Ecuador, de donde han salido cientos de personas en busca de ir a la Unión Americana para mejorar su calidad de vida. “Nosotros, si logramos vamos a avanzar, nos vamos a reunir con más migrantes que están en la ruta migratoria, porque hay muchos dispersos quienes podríamos tomar la bestia, si es que podemos para caminar más rápido”. Los migrantes que salieron en este nuevo contingente de personas, van custodiados por dos patrullas de la policía municipal, quienes le recomiendan a los migrantes que caminen a la orilla de la carretera para evitar ser atropellados. Las autoridades mexicanas a través del Instituto Nacional de Migración de México desplegarán un operativo de contención para asegurarlos y evitar que caminen y no arriesguen sus vidas en su travesía a los Estados Unidos. De Tapachula salieron más de 200 caravanas de migrantes de distintos países en busca de llegar a la frontera norte que colinda con Estados Unidos, las cuales en su mayoría fueron aseguradas y devueltas a esta ciudad fronteriza con Guatemala.


Huyen de sus país en crisis para alcanzar una mejor calidad de vida,pero parece imposible

CDMX.- El presidente Andrés Manuel López Obrador agradeció a los diputados de Morena y sus aliados en San Lázaro por avalar la iniciativa, sostuvo que “ahora pasa a la Suprema Corte y ahí van a decidir si es inconstitucional o no.

Al referirse al tema, pero sin ahondar en la denominada “cláusula de vida eterna” que permitía el traspaso de votos entre partidos y cuya discusión fue pospuesta para febrero, el ejecutivo Federal reiteró que la legislación presenta limitantes debido a que los partidos de oposición rechazaron la iniciativa de reforma constitucional que planteó su administración.
Posteriormente, López Obrador enumeró los puntos claves que presentaba la propuesta de reforma constitucional, y que no pudieron ser incluidos en la reforma a las leyes secundarias avalada en el Congreso: se planteaba reducir el
presupuesto de los partidos a la mitad, o alcanzar ahorros por 15 mil millones de pesos por la reducción del aparato electoral, con lo que, dijo, se podrían construir más de 100 centros de rehabilitación para personas con discapacidad. Tampoco se aprobó la eliminación de los 200 diputados plurinominales que no son elegidos por el pueblo, “sino eran parte de las cúpulas de poder de los partidos, eran para comprar conciencias, lealtades, para tener a los amigos, a los familiares, y no representar de verdad al pueblo, sino estar ahí de vividores. Pues queríamos quitar; no se pudo”.
Además, lamentó que entre quienes defendieron que permaneciera el Instituto Nacional Electoral sin modificaciones, hubo gente “de buena fe” que se dejó manipular, ya que les metieron en la cabeza que lo que buscaba su gobierno era “apoderarse” del órgano comicial, manejar el padrón electoral o incluso que él pudiera relegirse.
 COMUNICADO-EL SIE7E
COMUNICADO-EL SIE7E
CDMX.- El secretario de Gobernación, Adán Augusto López Hernández, es un firme defensor de los ideales de la Cuarta Transformación y de la labor que desempeña el presidente Andrés Manuel López Obrador, el segundo mandatario con mayor aceptación a nivel mundial.
López Hernández, quien es uno de los candidatos presidenciables predilectos por Morena rumbo a las elecciones del 2024, está pendiente de las políticas del gobierno federal, a través del cumplimiento del Plan Nacional de Desarrollo. Aunado a que Adán Augusto López Hernández es el hombre del confianza del presidente Andrés Manuel López Obrador también comparte con él el mismo pensamiento de combatir a toda costa la corrupción y ayudar en todo momento a los que menos
tienen.
Asimismo, es un férreo defensor y promotor de las tareas que desarrolla el mandatario federal, pero sobre todo es un gran conciliador, mediador, generador de acuerdos, diálogo y contribuye a mantener el equilibrio entre Poderes, experiencia política y talento que en pocos secretarios de Gobernación se había visto en la historia de México.
A Adán Augusto solo le bastó unos meses, tras asumir la titularidad en la Segob, para ser centro de atención mediática y aparecer inmediatamente después en las encuestas que buscan definir la preferencia del electorado rumbo al 2024.
Por todo lo anterior, queda claro que el secretario de la política interior de México no solo es candidato, si no una excelente opción para obtener la victoria en las urnas en las próximas elecciones presidenciales.
Tapachula.- En cumplimiento al artículo cuarto constitucional de que toda persona tiene derecho a la protección de la salud, en Chiapas se brinda atención médica a quien lo requiera, sin importar nacionalidad, por lo que en este año se han otorgado servicios a más de 5 mil migrantes en el Hospital General de Tapachula, dio a conocer el secretario del ramo en el estado, doctor Pepe Cruz.
En el marco del Día Internacional del Migrante, que se celebra el 18 de diciembre, el encargado de la política sanitaria a nivel estatal manifestó que al ser frontera y puerta de entrada de Centroamérica, la entidad es paso obligado o incluso de permanencia de población migrante, que en ocasiones tiene la necesidad de recurrir a los servicios de salud.
En ese sentido, mencionó que con corte a octubre de este año, el Hospital General de Tapachula ha brindado atención en urgencias generales y toco quirúrgicas a más 5 mil personas migrantes, provenientes de los países de Guatemala, Honduras, Haití, El Salvador y Venezuela, quienes ocupan el 85 por ciento de la de -
manda de atención global de los servicios de urgencias.
En urgencias generales, los migrantes con mayor demanda son de nacionalidad hondureña, guatemalteca y salvadoreña;
mientras que en el servicio de urgencias tocoquirúrgicas, Guatemala, Honduras y Haití son los países con mayor registro de atenciones.
Respecto a los nacimientos, se han re -
gistrado 950 partos en el mismo periodo, donde mujeres embarazadas de Guatemala ocupan el 60 por ciento de las atenciones, y junto con Haití, Honduras y El Salvador, concentran el 97 por ciento de los nacimientos atendidos.
Con relación al tema, el titular de la Secretaría de Salud en el estado agregó que de acuerdo con el reporte final de actividades presentado por el Comité para la Atención Integral a Migrantes del Distrito Sanitario número I, en las intervenciones que se hicieron durante el año en las instalaciones del Instituto Nacional de Migración en Tuxtla Gutiérrez, se brindaron 8 mil 600 atenciones médicas y psicológicas a personas adultas, adolescentes y embarazadas.
Dijo que los servicios otorgados también incluyeron vacunación contra varias enfermedades, detecciones de paludismo, pláticas sobre manejo higiénico de alimentos y saneamiento básico, entre otros. El doctor Pepe Cruz puntualizó que es premisa fundamental de este gobierno la realización de acciones para garantizar el acceso efectivo, universal y gratuito de la población a los servicios de salud, especialmente de la población marginada y migrante.
Cadenas, en donde se siguen implementando políticas de austeridad, racionalidad y disciplina del gasto público, por lo que en este momento, se tienen finanzas sanas y credibilidad financiera.
“No lo decimos nosotros, sino agencias internacionales expertas en finanzas que nos revisan y ahora nos dan estas calificaciones que dan confianza a los inversionistas externos y también a todas y todos los empresarios. En Chiapas, en materia de finanzas, se están haciendo las cosas con normatividad y transparencia”, afirmó.

Tuxtla.- Este fin de semana, se llevó a cabo el Consejo Estatal Ordinario de del Partido Movimiento Regeneración Nacional (Morena), encabezado por el presidente del Comité Ejecutivo Estatal del partido en Chiapas, Carlos Molina, donde se atendieron diferentes temas relacionados con las y los consejeros estatales.


Tuxtla.- Si se trabaja en conjunto, la sociedad organizada y el gobierno, es seguro que estaremos avanzando en beneficio de todas y todos los chiapanecos, sostuvo el secretario de Hacienda, Javier Jiménez Jiménez, al reunirse con las y los socios de
la Confederación Patronal de la República Mexicana (Coparmex Chiapas).
Durante un dialogo franco y abierto, el administrador de las finanzas estatales, hizo un recuento sobre la situación financiera que prevalece en la entidad, a cuatro años de asumir la gubernatura Rutilio Escandón
Javier Jiménez escuchó con interés y atención las participaciones de los que integran la Coparmex, encabezado por su presidente Manuel Felipe Pardo Pastrana, quien agradeció esta retroalimentación, así como la disposición para responder a todas las dudas de los socios y los diversos planteamientos presentados sobre el presupuesto 2023.
En su participación, el dirigente de Morena en Chiapas llevó un mensaje de unidad a las y los asistentes, destacando que sin importar “la cacería” que el Instituto Nacional Electoral (INE) ha desatado en contra de Morena no podrá detener el avance, además de expresar que la oposición ya está moralmente derrotada y próximamente también lo estará electoralmente.
Indicó que en esta reunión se dieron cita todas y todos los protagonistas del cambio verdadero de todo el estado, quienes serán las y los encargados de dar continuidad a esta nueva forma de gobierno.
Posteriormente, Carlos Molina citó
una estrofa del himno a Chiapas “que se olvide la odiosa venganza que termine por siempre el rencor”, exhortando así a mantenerse en unidad y trabajo, para seguir haciendo de Morena la primera fuerza política a nivel nacional, donde Chiapas es un gran bastión. En ese sentido, destacó la importante labor que han realizado el gobernador Rutilio Escandón Cadenas, así como el presidente Andrés Manuel López Obrador, que en conjunto están trabajando para hacer de Chiapas un mejor estado. Finalmente, llamó a que este año nuevo 2023 se redoblen esfuerzos en recorrer cada rincón de la entidad para llevar el mensaje de unidad y esperanza de la Cuarta Transformación.
Tuxtla.- La asociación civil Fomento Económico de Chiapas (FEC), dio a conocer que, en este 2022 la informalidad laboral en Chiapas durante el tercer trimestre de 2022 fue del 77.7 por ciento.


Esto superó al porcentaje nacional, que fue de 55.6 por ciento. En este informe se dio a conocer que, la tasa de la población económicamente activa ocupada sin acceso a la salud en la entidad es del 84.1 por ciento, mientras que a nivel nacional es del 60.9 por ciento. Indicó que Chiapas ocupa el lugar número 31 con una cifra de
afiliados del 11.04 por ciento en el ranking nacional del porcentaje de la población ocupada económicamente activa afiliada al Instituto Mexicano del Seguro Social (IMSS).
Cabe señalar que dicho ranking lo encabezan en primer lugar la Ciudad de México con 75.38 por ciento de afiliados al IMSS, seguida de Querétaro con 65.76 por ciento y el tercer lugar le corresponde a Nuevo León con el 64.94 por ciento.
Sin embargo, no todo es negativo, ya que el observatorio señaló que en Chiapas el porcentaje de población subocupada pasó de 10.3
por ciento hasta el tercer trimestre de 2021 a 8.8 por ciento durante el tercer trimestre de 2022.
En ese sentido, destacó que del año 2015 a la fecha el crecimiento de trabajadores asegurados en el IMSS en Chiapas ha sido del 9.78 % pues se pasó de 218 mil
* Como parte de las instrucciones del gobernador, Rutilio Escandón Cadenas, de llevar justicia social a todos los municipios de Chiapas
Socoltenango.- En cumplimiento al Plan Estatal de Desarrollo 20192024, que dirige el gobernador Rutilio Escandón Cadenas, de llevar justicia social a todos los municipios, pero sobre todo, de supervisar cada uno de los proyectos que se desarrollan en Chiapas, el secretario Ángel Torres supervisó la ampliación de la red de electrificación y la construcción de polideportivo en el municipio de Socoltenango.
Desde la comunidad de Emiliano
Zapata y en compañía del presidente municipal de Socoltenango, Carlos Morales Hernández, así como de pobladores; el secretario Ángel Torres supervisó la ampliación y rehabilitación de la red de energía eléctrica, cuya obra, dijo, no es más que justicia social.
En otro momento y en la comunidad de Benito Juárez, Ángel Torres y familias del lugar corroboraron el avance de la construcción del polideportivo, que comprenden dos canchas, una de ellas con domo, donde pronto las niñas, niños y jóve-
nes, tendrán un espacio digno para practicar actividades deportivas y de sana convivencia.
En este contexto, el secretario Ángel Torres sostuvo que estas obras son parte de las instrucciones del gobernador, Rutilio Escandón Cadenas, quien está transformando la vida de las y los chiapanecos y está llevando justicia social a todos los rincones de Chiapas, por lo que nosotros, añadió, “nos toca a seguir trabajando con alma, corazón y vida, y lo hacemos con mucho gusto y por amor a Chiapas”.
917 afiliados a 240 mil 323 en 2022.
A nivel nacional se ha dado a conocer que, Chiapas es el estado donde prevalece la informalidad laboral debido a sus condiciones socioeconómicas.
En la capital chiapaneca, los mis-
mos empresarios han dado a conocer que, tan sólo en el centro de la ciudad existe más de 5 mil vendedores informales, la presencia de vendedores de diferentes municipios, así como de otros estados se ha disparado en los últimos tres años.
Tuxtla .- De acuerdo con organizaciones, al cierre de este 2022, se ha denunciado un incremento considerable de elementos de la Guardia Nacional en puntos de tránsito de migrantes y en las mismas estaciones migratorias, en el estado de Chiapas.

El Colectivo de Observación y Monitoreo de Derechos Humanos en el Sureste Mexicano (COMDHSEM), destacó que, los elementos de fuerzas armadas en la frontera sur, de la Marina, y de la GN, así como mayor presencia de militares de Estados Unidos en Tapachula, genera tensión por un lado y normalización por otro, al tiempo que inhibe e intimida a las personas migrantes.
“Se han intensificado las barreras para acceder al asilo y la regularización migratoria, lo que ha generado que las personas migrantes, tomen opciones y rutas cada vez más peligrosas que ponen en riesgo su vida e integridad, además de las violencias específicas a que se enfrentan las muje-
res y niñas, y personas de la diversidad sexual”, expone el colectivo.
Destacó que, en el estudio “Panorama de Derechos Humanos desde la frontera sur de México 2022”, el COMDHSEM, expuso que se identificó diversas acciones de uso de la fuerza para la contención migratoria, siendo la más usual la restricción de desplazamiento al establecer perímetros de contención, seguido por la persuasión.
Aunque las acciones de inmovilización, el uso de fuerza física y de uso de armas no letales o “menos letales” se han identificado en menor proporción, “es preocupante su uso en contra de grupos donde hay bebés, niñas, niños, adolescentes, mujeres embarazadas y personas con discapacidad.” Cabe recordar que, la CNDH emitió dos recomendaciones a la Guardia Nacional por abusos contra migrantes en Chiapas, por ello, el reclamo de los organismos defensores de derechos humanos es a dar un trato humanizado a las personas en situación de movilidad.
Señalan incremento de acoso contra comunidad migrante en Chiapas
 CARLOS LUNA -EL SIE7E
CARLOS LUNA -EL SIE7E
Tuxtla.- Este fin de semana, Mario Arturo Acero Sandoval, doctor en ciencias, responsable del “Plan Estatal para la Interrupción de la enfermedad de Chagas en Chiapas, consideró que, el 80 por ciento de los casos de Chagas que existen se dan por trasmisión vectorial por la chinche, es por ello que exhortó a la población chiapaneca a mantener espacios limpios para evitar esta enfermedad que, en etapa avanzada es mortal.
A nivel local, esta chinche tiene presencia en zonas rurales y en las colonias de la periferia de Tuxtla, es de hábitos peridomiciliares, y cercanas al cerro de Mactumatzá.
Lamentablemente es difícil saber cuántos casos existen realmente, pues los síntomas graves suelen aparecer hasta 15 años después.
“Personal de la Secretaría de Salud, lleva cabo la detección de la chinche, se hace la búsqueda intencionada casa por casa y al momento en que se encuentra dentro
o fuera de la casa es colectada, se manda al área de entomología médica del Laboratorio Estatal de Salud Pública”, especificó.
En esta área, los especialistas llevan a cabo la identificación taxonómica, es decir se determina si la chinche representa un riesgo para la salud o no, se descarta o confirma si esta chinche contiene el parásito que provoca la enfermedad.
Por otro lado, también se llevan a cabo acciones de rociado residual, en viviendas donde se ha localizado la presencia de este insecto, se aplican insecticidas que no son tóxicos a la salud de los seres humanos y se prepara para el próximo año el plan de contención.
“Cuando una persona es picada por la chinche, ocurre un enrojecimiento en el área, a lo largo de 3 a 7 días presenta dolor. Esta enfermedad es silenciosa, tiene dos fases; la aguda y la crónica, es decir el inicio que suele confundirse con otros padecimientos pues se
presenta dolor de cabeza y temperatura. La fase crónica se detecta años más tarde, se presenta daños en diferentes órganos como el agrandamiento del corazón y otros órganos vitales.
“Es una enfermedad mortal. Se tiene conocimiento que en todo el mundo existe entre 7 y 8 millones de personas están infectadas por este parásito. Las autoridades de salud en conjunto con la Cenaprese, cuenta con el medicamento específico pata tratar la enfermedad que se detectan positivas siempre y cuando sea en una fase temprana y el medicamento pueda hacer su función, cuando se aplica en tiempo tiene muy buenos resultados”, explicó.
Informó además que, esta chinche se localiza en casas humildes, las que son un poco olvidadas, casas poco aseadas por dentro y por fuera, es donde el insecto tiene mayor presencia, por ello es de suma importancia, limpiar espacios donde se acumula leña, y que permanecen con poca iluminación.
Tuxtla.- Para la Secretaría de Medio Ambiente e Historia Natural la investigación científica es un tema primordial para desarrollar y difundir el conocimiento necesario para conocer, comprender y proteger a la naturaleza, por este motivo ha impulsado a trabajadores que puedan desarrollarse en ese ámbito. En este contexto se dio a conocer que la Dra. Nayely Martínez Meléndez, Curadora General del Orquidiario y Jardín Botánico “Comitán” de la SEMAHN, ha sido distinguida como Investigadora Nacional Nivel I de acuerdo con los resultados de la convocatoria 2022 para ingreso, permanencia o promoción en el Sistema Nacional de Investigadores (SNI), La Dra. Martínez Meléndez es la única mujer en la SEMAHN que cuenta actualmente con esta distinción, esto visibiliza la participación de la mujer en la investigación científica en la institución, donde además se promueve la investigación y divulgación de la ciencia en materia ambiental y biodiversidad en nuestra región, se fortalecen los grupos de investigación de alto
nivel académico en todas las entidades federativas y se impulsa la colaboración en grupos de investigación a nivel internacional. Sus líneas de investigación son la ecología de epífitas vasculares, la florística, el manejo de colecciones científicas y el manejo y conservación de orquídeas silvestres.
Ha documentado la riqueza florística de áreas naturales protegidas como las reservas de la biósfera El Triunfo y Volcán Tacaná la cual ha sido base para la gestión y conservación de la Sierra Madre de Chiapas. Como autora o coautora ha trabajado en 47 publicaciones, incluyendo 25 artículos con factor de impacto, dos libros como editora, autora de un libro de divulgación, ocho capítulos de libro y siete artículos de divulgación científica y cuatro con arbitraje.
Ha participado en diversos congresos, simposios, estancias aca-
démicas y talleres nacionales e internacionales, con actividades de florística y ecología vegetal. Durante el 2017 al 2021 participó en proyectos comunitarios relacionados con la conservación de recursos forestales y manejo de orquídeas en colaboración con la Comisión Nacional de Áreas Naturales Protegidas. Cabe mencionar que el Gobierno Federal por medio del Consejo Nacional de Ciencia y Tecnología (CONACYT) otorga esta distinción a través del Sistema Nacional de Investigadores a los científicos, humanistas y/o tecnólogos que hayan sobresalido por la calidad de su producción de investigación científica, en la formación de comunidad científica, así como por su aportación al fortalecimiento de la investigación científica, del país a través del acceso universal e incidencia en problemas sociales.

Mariano Rosales coloca a Fátima Urbina banda de Reina electa de la Feria Villaflores 2023
Villaflores.- Este sábado se llevó a cabo la elección de la Reina de la Feria Villaflores 2023 en la que salió electa Fátima Urbina en una reñida competencia entre todas las aspirantes, Lili Gordillo con su porra morada, Erika Sánchez Méndez porra verde, Bere Chanona porra azul, Lizeth Interiano porra rosa, Gaby Gamboa porra roja y Azul Molina porra amarilla. Hubo dos pasarelas, una con ropa casual y otra con ropa de noche, el jurado calificador estuvo integrado por Miss Teen Tuxtla 2022 Daniela Matuz, Silvia García Miss Turismo 2022 y el director de Miss Teen Chiapas Yair Avendaño, mismos que calificaron desenvolvimiento escénico, elegancia y actitud.

Todas las aspirantes recibieron ovación y apoyo en redes sociales y reconocimiento del público por su participación, les fue entregado un arreglo floral y banda como reconocimiento a Azul Molina como Señorita Elegancia y Redes Sociales respectivamente, como Señorita Simpatía Gaby Gamboa y como Señorita Fotogenia fue Bere Chanona.
La Reina saliente María Fernanda Macías, se despidió agradeciendo del alcalde Mariano Rosales Zuarth,
de su esposa Margarita Sarmiento y del público, dijo sentirse muy contenta por haber vivido la experiencia de ser reina y proyectar la cultura y las tradiciones de Villaflores.
Al final del evento se proyectó un video en donde se dio a conocer la cartelera oficial de los artistas que se presentarán en el masivo de Feria Villaflores 2023, del 11 al 15 de enero, el día 11 se presenta Lupillo Rivera, el 12 Cardenales de Nuevo León, el 13 la Sonora Dinamita, el 14 Banda la Ejecutiva y el día 15 Los Tucanes de Tijuana.
Tuxtla.- El incremento de los hechos delictivos, en los últimos tiempos, se traduce en una evidente descomposición social, aceptó Fabio Martínez Castilla, arzobispo de la Diócesis de Tuxtla Gutiérrez. Manifestó que cuando se hace a Dios a un lado, la gente “endurece su corazón y se vuelve contra su propio hermano, padre e hijos, y eso es lo que está ocurriendo” en la actualidad en la sociedad.
Aclaró que, en ese sentido, la violencia se exacerba entre las personas, “es un trabajo difícil, que lleva un proceso muy largo; pero cuando volvamos nuestra mente y corazón al Todopoderoso, recuperaremos muchas cosas”. Aunque destacó que los gobiernos tienen una parte de la culpa de la descomposición social, resaltó que muchas veces hay personas o grupos que solo pueden ser controlados con un poco de fuerza.
“Si no se usa esa fuerza, todo se voltea, y resulta que esos
SCLC.- Durante la realización del Séptimo Festival de Graffiti-Arte-Mural se destacó la participación de Maruch Méndezc Artista maya/tsotsil, Artista de naturaleza profunda, ya que sus obras son una conexión entre lo espiritual y material, una evocación de un mundo híper-imaginario, donde se entrelaza la relación hombre-naturaleza.
“estuve muy contenta, No es gran cosa lo que hago en las calles, estuve contenta durante los 4 días, es la primera vez que pinto en la calle pero
estoy contenta, aunque mi mural no es tan bonito, es muy sencillo pero lo hice”, fue lo que dijo durante su participación en la clausura de las actividades del Festival de Graffiti-Arte-Mural Y es que el Colectivo Independiente “Ch’ulel” llevó a cabo durante 4 días con el apoyo del coordinador Dyg’nojoch, artista urbano maya-tsotsil, oriundo de Chenalhó pero radicado desde hace años en esta ciudad, el Séptimo Festival de Graffiti-Arte-Mural en la que se realizaron murales en las fachadas de instituciones educativas en la Colonia Prudencio Moscoso, en la

zona norte de esta ciudad. Desde joven Maruch, comenzó su práctica artística en retomar la terracota, en la creación de objetos utilitarios y de usos tradicionales. Sin embargo, gracias a su sabiduría mítica e histórica de sus ancestros, ella comenzó a perfeccionar un estilo personalizado de gran sencillez y relevancia. Durante las actividades de cierre, se dio a conocer su trayectoria comenzó en Taller Leñateros, trabajando con la poeta Ámbar Past y el colectivo de mujeres, manufacturas de libros de artista.
grupos delictivos, esas malas personas, agarran más campo, más terreno, y es más complicado para el pueblo porque éste no se siente protegido por sus autoridades”, puntualizó.
De hecho, llamó a las fiscalías a hacer sus trabajos de investigación, y que de esa forma llegue la justicia, “porque sin ésta, sumado a la corrupción que va en crecimiento, es lo que nos hace mucho daño”. Incluso, destacó que es tan compleja la situación actual que ha habido amenazas en algunas iglesias, “por fortuna, los padres han sabido cómo ‘torearlas’; pero este ambiente (de violencia) es generalizado”.
Para contrarrestar esta problemática, dijo que es necesario que la sociedad y gobierno trabajen de la mano para esa construcción de la paz, “pues los narcos tienen más fuerza porque se han posicionado de más terreno; no hay policías, no hay espacios de seguridad, y por desgracia la descomposición social es evidente”.

Tuxtla.- La presidenta del Consejo Político Estatal de Morena en Chiapas, Flor Esponda Torres, afirmó que su partido vive una etapa de consolidación y materialización gracias al trabajo en unidad que realizan pueblo y Gobierno.

La también legisladora local, abundó que Morena trabaja día a día para que los más desposeídos económicamente hablando les vaya mejor y tengan mejores oportunidades laborales, educativas y económicas. Tras participar en el Consejo Político Estatal de este instituto político, Esponda Torres expuso que seguirán recorriendo los municipios al lado del pue -
blo, porque sólo caminando junto a ellos se pueden conocer y palpar las necesidades de la gente.
Remarcó que desde el Congreso del Estado también se han impulsado iniciativas en favor de los grupos vulnerables y en lo que resta de la administración continuarán con la misma dinámica proactiva. Reiteró su reconocimiento al presidente Andrés Manuel López Obrador así como al gobernador Rutilio Escandón Cadenas, quienes han encausado las demandas más sensibles del pueblo de México y Chiapas, respectivamente , prueba de hoy es que se vive la Cuarta Transformación de la Vida pública del País.


El gobernador sostuvo que se cuenta con un sistema de salud fuerte, que garantiza el acceso a servicios médicos dignos y con perspectiva cultural y de género Anunció que la entidad contará con 16 unidades médicas de este tipo; se caracterizan porque todas las que laboran en ellas son mujeres ·Resaltó que, con respaldo de AMLO, a la fecha se ha reconvertido más del 60 por ciento de la infraestructura de salud estatal, y la meta es lograr el 100 por ciento
COMUNICADO-EL SIE7ESCLC.- Al inaugurar la Clínica para la Atención de Parto Humanizado de San Cristóbal de Las Casas, el gobernador Rutilio Escandón Cadenas sostuvo que es satisfactorio constatar que gracias a las inversiones en este rubro, hoy Chiapas cuenta con un sistema de salud fuerte y moderno, que garantiza el cumplimiento del derecho humano del pueblo de acceder a servicios médicos dignos, de calidad y con perspectiva cultural y de género. “Hoy Chiapas tiene Clínicas para la Atención de Parto Humanizado en Tuxtla Gutiérrez, Huixtla y San Cristóbal de Las Casas, y nuestra meta es seguir ampliando esta red de salud especializada; pues el mayor deseo es brin -
dar a las mujeres embarazadas, el acceso a servicios eficaces y oportunos, donde se sientan tranquilas y seguras durante el proceso de embarazo, parto y posparto. Tengan la confianza de que seguiremos invirtiendo para brindar una vida plena a las mujeres y las niñas chiapanecas”, expresó.
Destacó que su gobierno no escatimará recursos en materia de salud, por ello anunció que con el objetivo de dar cobertura a los 10 Distritos de Salud, Chiapas contará con 16 unidades médicas de este tipo, que tienen la principal característica de que todo el personal que labora en ellas está confirmado por mujeres, desde dirección, especialistas, enfermería, entre otros, pues el deseo es cuidar la intimi -
dad y brindar atención obstétrica calificada, según las costumbres y creencias de las pacientes. Tras resaltar que gracias al respaldo del presidente Andrés Manuel López Obrador en tan sólo cuatro años de gobierno se ha ampliado, reconvertido, equipado y mejorado integralmente más del 60 por ciento de la infraestructura de salud, tanto en las zonas urbanas como rurales, y la meta es no detener la marcha hasta lograr el 100 por ciento, el mandatario exhortó al personal de salud y a la población a sumarse al cuidado de estas instalaciones sanitarias, pues representan un patrimonio del Estado.

En su intervención, el secretario de Salud, José Manuel Cruz Castellanos, informó que se
tiene programado que este año se concluya con la construcción de las primeras 10 clínicas de este tipo, y para el primer cuatrimestre del 2023 la edificación de seis más, a fin de que en todo el territorio estatal no falte esta atención humanizada que tanto se requiere, sobre todo cuando se trata de la mujer.
“Estamos conscientes que muchas mujeres se dedican a su hogar, salen a trabajar, cuidan su familia y son verdaderamente el pilar de una casa; por ello, redoblamos los esfuerzos y recursos para consolidar esta clase de clínicas, las cuales cuentan con personal especializado y la tecnología de primer nivel”, apuntó.
En nombre de las beneficiadas, Ixchel Montserrat López Martí -
nez, externó su satisfacción por ser parte de la operación de este centro hospitalario, mediante la cual, dijo, “nos regalan el privilegio de acceder a instalaciones vanguardistas y de primer nivel, con el objetivo de hacernos sentir cómodas durante el embarazo y el parto; nos regalan la posibilidad de que el momento más lindo de nuestras vidas estemos rodeadas de confort y acompañamiento”.
Finalmente, el alcalde de San Cristóbal de Las Casas, Mariano Alberto Díaz Ochoa señaló que este acto es una muestra de que el Gobierno de Chiapas trabaja con responsabilidad y alto sentido humanitario, a favor del bienestar de la población, especialmente de las mujeres y las niñas chiapanecas.

Lunes 19 de diciembre de 2022
www.sie7edechiapas.com
CDMX.- Con un 34.2 % de preferencia, el secretario de gobernación Adán Augusto López se pone en segundo lugar de preferencias rumbo a las elecciones del 2024.

La encuestadora “México Elige” pregunta cuál de los
presidenciables consideran el favorito del presidente, posicionando a la jefa de gobierno de la Ciudad de México, Claudia Sheinbaum, con un 45 % y a Marcelo Ebrard muy por debajo, con poco más del 20 %. Esta tendencia situaría a Adán Augusto López en una consideración muy valiosa en torno a las preferencias electorales, estando ya prácticamente empatado

con Sheinbaum.
El secretario de gobernación se ha mantenido trabajando en torno al llamado Plan B de la Reforma Electoral, desestimando así la propuesta de debate entre presidenciables planteado por Marcelo Ebrard. “No son tiempos de proyectos políticos” afirmó el tabasqueño.
Ciudad de México.- A partir de este lunes, los niños y adolescentes mexicanos inscritos en escuelas primarias y secundarias públicas y privadas iniciarán su periodo vacacional de invierno, informó la Secretaría de Educación Pública (SEP).

De acuerdo con datos oficiales, 24 millones de estudiantes y 1,9 millones de trabajadores de la educación pública y privada se beneficiarán de los 10 días de vacaciones. Los días serán divididos en dos periodos que van del 19 al 23 y del 26 al 30 de diciembre próximos, así como de los días 2 al 6 de enero de 2023.
En los últimos cinco días inhábiles para los menores mexicanos se implementará, en las más de 232.000 escuelas públicas y privadas de las 32 entidades mexicanas, el Taller
Intensivo de Formación Continua para Docentes sobre los Nuevos Planes y Programas de Estudio para la Educación Básica.
“Las comunidades educativas de preescolar, primaria y secundaria, reanudarán actividades escolares presenciales el próximo lunes 9 de enero de 2023”, detalló la SEP.
Por su parte, la dependencia mexicana refirió que alrededor de 4,8 millones de estudiantes y casi 413.000 docentes de planteles de Educación Media Superior retomarán actividades hasta el próximo 2 de enero de 2023 en más de 20.800 centros educativos.
Para el nivel Superior, las autoridades escolares de los más de 5.800 planteles determinarán las fechas en las que estudiantes y docentes regresarán a las aulas.
Asimismo, la SEP recordó que el calendario escolar es de 190 días, correspondiente al ciclo lectivo 2022-2023, y el
cual es aplicable para escuelas de educación preescolar, primaria y secundaria incorporadas al Sistema Educativo Nacional de México.
De acuerdo con los calendarios de la Universidad Nacional Autónoma de México (UNAM) y el Instituto Politécnico Nacional (IPN), estas universidades públicas retomarán actividades desde el 4 y 5 de enero próximos, respectivamente.
EFE · EL SIE7ETijuana.- Pese a que este año la Secretaría de Gobernación (Segob) detectó un incremento del 32% de “personas en situación migratoria irregular”, en la fronteriza Tijuana, al norte de México, los que acapararon los albergues y las instancias de apoyo fueron los migrantes desplazados por la violencia y el crimen organizado de estados mexicanos como Michoacán y Guerrero.

Activistas consultados por EFE coincidieron en que este año el flujo de estas personas incrementó hasta en un 50 %, en comparativa con el año pasado, como lo hizo saber José María García Lara, director del albergue Movimiento Juventud 2000, quien consideró que “esto es una clara muestra de lo grave de la problemática de violencia que tiene el país”.
Para el activista, el dato del incremento en cuanto a población migrante de otros países es revelador porque es señal de que sigue saliendo la gente de sus lugares de origen pese a las inhibiciones que el gobierno de Estados Unidos está realizando para procesar solicitudes de
asilo. Sin embargo, consideró también que “al ser detectadas por autoridades nacionales quizá ni alcanzaron a llegar a la frontera”.
“Lo preocupante es que este año tuvimos un incremento de mayor consideración con los desplazados por la violencia, principalmente de estados como Michoacán y Guerrero, pero eso no lo contabiliza el Gobierno federal porque es interno y no lo están asumiendo por ello”, dijo.
El pastor Albert Rivera, director del albergue Ágape Misión Mundial coincidió, pues se dijo sorprendido de que la mayoría de inmigrantes y refugiados que
llegan a Tijuana son mexicanos. “Hay más gente mexicana pidiendo asilo que gente de Guatemala, Honduras, El Salvador, lo cual es preocupante”, comentó. Rivera detalló que, tan solo en 2021, en su albergue atendieron alrededor de 1.000 migrantes procedentes de estados como Michoacán y Guerrero, “y este año fácil hemos atendido alrededor de 3.000, lo cual habla de un incremento de más del 50 %, y muchos de ellos, en familias completas a las cuales amenazaron, secuestraron, asesinaron y torturaron”.
“Es una situación gravísima. Uno, pensando mal, pensaría
que hay un interés político en que haya más desplazados porque se van las personas y se obtienen remesas y el presidente ha presumido mucho de ello”, señaló.
Por su parte, García sostuvo que en ese tema “hay mucho que pensar, mucho que trabajar, principalmente en las comunidades de origen de estas personas.
Afirmó que lo esencial es erradicar la violencia y brindar las garantías de vida a sus habitantes; conocer las necesidades y crear ambientes fuera de la violencia para los migrantes porque “desafortunadamente
vemos que el crimen cada vez gana más terreno”.
Para los activistas, el hecho de que este año también se estuvieran generando diversos movimientos migratorios, se debió principalmente al constante cambio en las políticas migratorias de Estados Unidos, como sucedió con los venezolanos y con las leyes que constantemente cambiaron de parecer en cuanto al Título 42.
Rivera recalcó que los mexicanos “se dejaron venir en cascada por la violencia”, pero se dio el otro caso de que “Estados Unidos por dar constantemente mensajes mixtos y que la Corte estuviera diciendo una cosa y después otra, eso generó que de otros países se estuvieran aventurando también a llegar a la frontera intentando pasar a suelo estadunidense”.
“Ahora que están por quitar el Título 42 en próximos días, esperamos que se deje venir otra ola de migrantes”, anticipó.
El pastor mencionó que también se enfrentará un problema por la cantidad de solicitudes de asilo en el que no se sabe cómo se van a procesar por parte de las autoridades mexicanas.
 EFE - EL SIE7E
EFE - EL SIE7E
Ciudad de México.- Una reforma electoral permitiría que las personas en prisión preventiva voten sin obstáculos en los centros penitenciarios para los comicios presidenciales de 2024, reveló un estudio del Instituto Belisario Domínguez (IBD).
Desde 2019 las autoridades electorales mexicanas organizaron una primera prueba piloto para garantizar este derecho a toda esta población, siguiendo lo establecido en el estudio denominado “Modelos de votación electoral para las personas en prisión preventiva: países seleccionados”.
El Tribunal Electoral del Poder Judicial de la Federación (TEPJF) resolvió en 2019 que las personas en prisión preventiva tienen derecho a votar como cualquier otro ciudadano, aunque pierden esta garantía por su condición jurídica, según las leyes mexicanas.
En este sentido, el Instituto Nacional Electoral (INE) realizó una prueba piloto en 2021, a fin de garantizar dicha prerrogativa, lo cual tuvo un resultado de participación superior al 94 % en cinco centros penitenciarios mexicanos.
El estudio del IBD, perteneciente al Senado mexicano, y elaborado por los investigadores Juan Manuel Rodríguez y Miguel Ángel Barrón, reveló que dicho ordenamiento prevé que se garantice este derecho para las elecciones de 2024, cuando se elegirá a un nuevo presidente de México para un periodo de seis años.
Dicho análisis del IBD del Senado mexicano destaca que al menos cuatro países iberoamericanos como Argentina, Costa Rica, Ecuador y España ya cuentan con alguna normativa a partir de la cual se garantiza el derecho al voto de las personas en prisión preventiva.
Ciudad de México.- La balanza comercial agroalimentaria de México registró un superávit de 5.077 millones de dólares en los primeros 10 meses de 2022, informó la Secretaría de Agricultura y Desarrollo Rural (Sader) de México.
El superávit observado entre enero y octubre de este año fue el quinto mayor saldo positivo en 28 años, en términos monetarios, según cifras del Banco de México (Banxico).
En este mismo periodo, las ventas agroalimentarias al exterior rompieron récord, al sumar 41.602 millones de dólares, lo que significó un aumento de 13,88 %, en comparación con los 36.532 millones de dólares en el mismo periodo del año previo.
Este mismo volumen se acercan a la cifra total de ventas registrada en todo 2021, cuando ingresaron 44.687 millones de dólares pro productos agropecuarios y agroindustriales.
La Sader detalló que las importaciones agropecuarias totaliza -
ron 36.525 millones de dólares en los primeros 10 meses del año.
La dependencia mexicana señaló que, si bien las importaciones registraron crecimiento a octubre pasado, “se ubican por debajo del nivel de las exportaciones, con lo cual la balanza se mantiene superavitaria”.
“Así, el comercio agroalimentario de México con el mundo sumó 78.127 millones de dólares en el periodo enero-octubre, donde el 53,2 % correspondió a las ventas de nuestro país (México) a sus socios comerciales”, detalló la Sader en un comunicado.
En contraste, la Secretaría de Agricultura de México indicó que solo la balanza agropecuaria y pesquera presentó un déficit por 208 millones de dólares. Esto, como resultado de un total de exportaciones por 17.541 millones de dólares y compras al exterior por 17.749 millones de dólares.
En tanto, refirió que la balanza agroindustrial tuvo un superávit por 5.285 millones de dólares, al registrar ventas al exterior por 24.061 millones de dólares
e importaciones por 18.776 millones de dólares.
En este sentido, las bebidas, frutas y hortalizas fueron los principales grupos de exportación al concentrar el 60 % del comercio exterior agroalimenta -

rio, con el 24,18 y 18 % de participación, respectivamente, en los primeros 10 meses del año.
Los productos con mayores incrementos en sus exportaciones fueron del trigo y morcajo con aumentos de más del 175 %,
seguidos por el cacao en grano (149,8 %); café sin tostar y sin descafeinar (86,99 %); azúcar (52,32 %); preparaciones de café, té o yerba mate (47,55 %) y aceite de girasol, cártamo, algodón (41,47 %).
Ciudad de México.- La iglesia católica en México pidió este domingo garantizar la labor informativa de periodistas y comunicadores de forma segura, sin presiones y violencia, tras el intento de asesinato al mexicano Ciro Gómez Leyva el pasado jueves.
“La violencia contra los medios de comunicación abarca más que solo los lamentables asesinatos: abarca censura, presiones de grupos de poder y condiciones laborales precarias para quienes realizan la invaluable labor de informar a la sociedad”, sentenció la Arquidiócesis Primada de México en la editorial de su semanario “Desde la Fe”.
La iglesia católica recordó que el Papa Francisco ha señalado que la misión de los periodistas es explicar el mundo, hacerlo menos oscuro, hacer que los que viven en él le tengan menos miedo y miren a los demás con mayor conciencia. En este sentido, la Arquidiócesis mexicana enfatizó que la violencia jamás debe de verse como una “excusa per -

fecta para solucionar los diferendos o los antagonismos”, frente a los años más devastadores para los periodistas en México, donde se estima que cada 14 horas se asesina a un comunicador.
“La agresión hacia un periodista no debe ser el método para tratar de acallar su opinión o la información que da a conocer”, añadió.
También exigió a las autoridades definir las estrategias y pasos a seguir para alcanzar la paz y l ajusticia en todo el territorio mexicano y con ello detener la
ola de violencia e inseguridad que afecta al país norteamericano.
La noche del pasado jueves, el periodista Ciro Gómez Leyva dio a conocer que un grupo armado intentó asesinarle al salir de su programa televiso y a unos metros de su domicilio en la capital mexicana.
El periodista que encabeza dos programas de radio y televisión en horarios estelares recibió varios impactos de bala, sin que pudieran alcanzarlo debido al blindaje que portaba su camioneta.
“A las 11:10 pm, a 200 metros de mi casa, dos personas en una motocicleta me dispararon, al parecer con la clara intención de matarme. Me salvó el blindaje de mi camioneta que yo manejaba y he enterado del asunto a las autoridades”, relató el comunicador en su cuenta de Twitter.
El pasado viernes, el propio presidente mexicano, Andrés Manuel López Obrador, condenó el ataque a balazos en contra del periodista Gómez Leyva. Desde el año 2000 hasta la fecha, Artículo 19 ha documentado 151 asesinatos de periodistas en México, en posible relación con su labor profesional, de los cuales 47 se registraron durante el mandato del presidente Enrique Peña Nieto (2012-2018) y 31 en el actual Gobierno (2018-2024).
La semana pasada, el Parlamento Europeo (PE) condenó las amenazas, el acoso y el asesinato de periodistas y defensores de los derechos humanos en México e instó a que estos crímenes se investiguen de manera “rápida, exhaustiva, independiente e imparcial”.






Lunes 19 de diciembre de 2022 www.sie7edechiapas.com
Lima.- El Gobierno de Perú declaró este domingo el toque de queda nocturno durante cinco días en la provincia de Huamanga, en la región de Ayacucho, tras las protestas y movilizaciones que esta semana dejaron nueve personas muertas en enfrentamientos entre manifestantes y las fuerzas de seguridad en esa localidad.

La medida, que fue refrendada mediante un decreto publicado en un boletín extraordinario de normas legales, ordenó la “inmovilización social obligatoria” en Huamanga entre las 18.00 hora local (23.00 GMT) y las 04.00 hora local (9.00 GMT) del
día siguiente. Señaló, sin embargo, que en el horario establecido “las personas pueden circular” para comprar alimentos, las farmacias atender al público, el libre tránsito de la prensa debidamente acreditada y el desplazamiento de vehículos y peatones que requieran de una atención médica de urgencia o adquirir medicamentos.
El decreto fue firmado por la presidenta Dina Boluarte; el primer ministro, Pedro Angulo; y los ministros de Defensa, Luis Otárola; Interior, César Cervantes, y de Justicia, José Tello. De esa manera, Huamanga se suma a la medida del toque de queda nocturno que el Gobier -
no ya ordenó el pasado jueves en otras 15 provincias de 8 de los 24 departamentos que tiene el país.
El Gobierno de la presidenta Dina Boluarte decretó el miércoles pasado el estado de emergencia a nivel nacional por 30 días para intentar controlar los actos de vandalismo y violencia cometidos en las manifestaciones de protesta en su contra. Durante el estado de emergencia, quedan suspendidos los derechos constitucionales relativos a la inviolabilidad de domicilio, libertad de tránsito por el territorio nacional, libertad de reunión y libertad y seguridad personales, detalló en su segundo artículo.
Este sábado, al menos cuatro de los nueve fallecidos en los enfrentamientos que se produjeron el jueves en Ayacucho fueron enterrados, mientras las autoridades sanitarias trasladaron a Lima a siete heridos y afectados durante el estallido de violencia en esa localidad.
El jueves una manifestación desencadenó en actos vandálicos y el intento de ocupar el aeropuerto regional, que fue repelido por policías y militares con armas de fuego, lo que dejó nueve muertos, tras el fallecimiento este sábado de otro de los heridos.
Las protestas comenzaron el pasado 7 de diciembre en varias regiones de Perú, sobre todo en
Lima y el sur andino, luego de que el Congreso destituyera a Pedro Castillo de la Presidencia del país tras intentar dar un golpe de Estado.
Los manifestantes exigen la renuncia de Boluarte y el cierre del Congreso, así como la convocatoria a elecciones generales y a una asamblea constituyente. Las cifras oficiales indican que hasta el momento han muerto 23 personas en diferentes zonas del país, mientras que el Ministerio de Salud informó que otras 77 personas permanecen hospitalizadas por los enfrentamientos, 29 de ellas en Ayacucho, 17 en Junín, 12 en La Libertad, 7 en Arequipa, 6 en Lima, 5 en Apurímac y 1 en Huancavelica.
Buenos Aires.- La grieta política existente entre el oficialismo y la oposición en Argentina se desintegró, al menos por este domingo, con la unanimidad de los líderes de las distintas formaciones felicitando a la selección de fútbol de Argentina.

Además de los mensajes publicados por el presidente del país, el peronista Alberto Fernández, quien habló de la ‘Scaloneta’ como “el ejemplo de que no debemos bajar los brazos” y de que el “gran pueblo” argentino tiene “un gran futuro”, otros líderes políticos expresaron su alegría en las redes sociales por esta victoria. La vicepresidenta dedicó buena parte de su mensaje a dar las “gracias infinitas” al capitán de la Albiceleste, Lionel Messi, “por la enorme alegría” que el equipo ha regalado “al pueblo argentino”.
Además, recordó el saludo “maradoniano” que, días atrás, ‘La Pulga’ dedicó a un jugador neerlandés después del duelo de cuartos de final, “andá pa’ allá bobo”, que, en opinión de la también exmandataria (2007-2015), hizo que se ganara “definitivamente el corazón de los y las argentinas”.
“Ah… ¡casi me olvidaba! Muchas gracias también por traer a la Patria la tercera copa”, agregó en alusión al tercer título mundial para Argentina, después de los de 1978 y 1986.
El también expresidente Mauricio Macri (2015-2019), presente en Catar por su rol en la Fundación FIFA, definió la final como “una exhibición de fútbol”. “Nos infartamos, volvimos a vivir, volvimos a morir y finalmente lloramos como niños de emoción. Gracias muchachos, gracias cuerpo técnico, esto es MARAVILLOSO! Vamos ARGENTINA, vamos Sudamérica!!!!!”, tuiteó el exdirigente del club Boca Juniors, quien se dijo
“afortunado” por “vivir en la época de Lionel y poder verlo jugar”.
“Orgullo es poco. Lo merecías más que nadie, gracias por traer la copa a los argentinos!!!!!”, apuntó el político conservador, fundador del partido Propuesta Republicana (PRO, centroderecha).
Por su parte, el ministro argentino de Economía, Sergio Massa, publicó un mensaje en sus redes sociales, en las que destacó el “coraje” y la “templanza” de la selección cuando se le complicó el resultado tras el 2-0 con el que llegó al descanso de la final contra Francia.
“Talento, orden y humildad. Orgullosos de ver que defendieron la celeste y blanca con el alma hasta el final. ¡Gracias campeones! ¡Te amo Argentina.
Gracias héroes!”, indicó el titular de la cartera económica.
La foto de Messi besando el trofeo de campeones del mundo fue tuiteada por políticos de signo contrario, como el actual canciller, Santiago Cafiero, y la exministra de Seguridad -y una de las seguras candidatas conservadoras a la Presidencia en las elecciones de 2023Patricia Bullrich.
También el alcalde de Buenos Aires, Horacio Rodríguez Larreta, cofundador del PRO y uno de los aspirantes en 2023 a presidir Argentina por la actual oposición nacional-, escribió en Twitter: “SOMOS CAMPEONES DEL MUNDO CARAJOOOOOOOOOO!!!!!! Qué Alegría!!!!!! Gracias Equipo!!!!!”. Además, publicó la foto de la selección elevando el título al cielo y escribió: “Esta imagen va a quedar inmortalizada en el corazón de todos los argentinos. Te merecés esto y más. GRACIAS, LEO”.
Argentina obtuvo su tercer título mundial -para sumar a los de 1978 y 1986tras vencer en la final a Francia en la tanda de penaltis (4-2) tras el empate 3-3 en el tiempo reglamentario.
EFE - EL SIE7EPekín.- La demolición de la política de covid cero en China ha dejado al país prácticamente paralizado, con calles vacías y colas en las farmacias, a un mes de las vacaciones por el Año Nuevo Lunar, que podría provocar un aumento aún más vertiginoso de las infecciones.
En grandes ciudades como Pekín, la eliminación de las restricciones ha desembocado en un alza de contagios que, sin embargo, no se refleja en las estadísticas oficiales -China informó este domingo de solo 2.097 nuevos casos de covid detectados en la víspera-, una vez abandonadas las pruebas PCR a las que los residentes debían someterse varias veces por semana para poder acceder a cualquier establecimiento público. La realidad es que muchos se quedan estos días “autocuarentenados” mientras se hacen test de antígenos y, según el cambio de política, aislarse en sus domicilios en caso de dar positivo en lugar de ser trasladados a centros de cuarentena como hasta hace apenas unas semanas. Otros hacen colas en las farmacias para hacer acopio de medicinas y comienzan a habituarse a convivir con el virus tras tres años de la política de ‘cero covid’, que consistía en el aislamiento de todos los contagiados y sus contactos cercanos, estrictos controles fronterizos, confinamientos y test masivos constantes a la población. Entretanto, los expertos pronostican que el país se encuentra “en la primera de tres oleadas” de casos de covid para este invierno, según explicó el sábado el epidemiólogo jefe del país, Wu Zunyou. “La primera ola se extenderá desde mediados de diciembre hasta mediados de enero y tendrá lugar principalmente en las grandes ciudades. La segunda ola la veremos a finales de enero y durará hasta mediados de febrero de 2023 a causa de los desplazamientos por las vacaciones por el Año Nuevo Lunar”, dijo Wu, recoge la agencia estatal Xinhua. Para hacer frente al aumento de contagios durante las vacaciones por el Año Nuevo Lunar, la mayor migración anual del mundo y que en 2023 caerán entre el 21 y el 27 de enero, el Ejecutivo ya ha pedido a los Gobiernos locales que den prioridad a los servicios de salud en las zonas rurales “para proteger a la población”, señalando “su relativa escasez de recursos de atención médica”, la alta movilidad durante las vacaciones y los viajes de los trabajadores migrantes que regresan a sus lugares de origen.

Según Wu, la tercera oleada se extenderá desde finales de febrero hasta mediados de marzo, tras el final de las vacaciones.
SIN FALLECIDOS EN LA PRIMERA OLEADA, SEGÚN EL GOBIERNO En sus recuentos oficiales, la Comisión
Nacional de Salud no ha informado de ninguna muerte por COVID desde el pasado 7 de diciembre, prácticamente en el momento en el que el país decidió recular de su anterior estrategia tras las protestas que había generado.
Según vídeos que circulan por las redes sociales, además de Pekín, otras ciudades como la suroccidental de Chengdu también presentaban estos días las calles desiertas, mientras que en la megalópolis oriental de Shanghái o en la meridional de Cantón las autoridades han decidido cerrar las escuelas hasta nuevo aviso para evitar una mayor propagación del virus.
En un inesperado giro, el Gobierno chino aseguró a principios de este mes que se daban las “condiciones” para que el país ajustara sus medidas ante una “nueva situación” en la que el virus provoca menos muertes, aunque también anunció un plan para acelerar la vacunación de los ancianos, uno de los grupos más vulnerables pero a la vez más reticentes a inocularse. Según la agencia Xinhua, casi el 87 % de los mayores de 60 años se han vacunado con la pauta completa, pero el porcentaje baja al 66,4 % entre los mayores de 80.
La prensa oficial comenzó igualmente hace unas semanas a minimizar el riesgo de la variante ómicron a través de numerosos artículos y entrevistas a expertos, un giro de argumento que acompañó a la relajación de algunas de las medidas más estrictas de la política de ‘cero covid’.v Los cambios llegaron después de que el hartazgo ante las restricciones cristalizase en protestas en diversas partes del país tras la muerte de diez personas en un edificio aparentemente confinado en Urumqi (noroeste), con consignas como “no quiero PCR, quiero comer” o “devolvedme mi libertad”.
El Gobierno ha defendido que ha salvado millones de vidas mediante el ‘cero covid’, y este mismo domingo Xinhua aseguraba en un editorial que China “ha honrado su palabra y puso a la gente y su salud en primer lugar”.
“China ha cambiado el enfoque de su estrategia de respuesta a la covid porque el patógeno se ha debilitado. Pero esto no va en contra de la cruda realidad, y es que es uno de los países del mundo que más vidas ha salvado durante la pandemia del mundo en términos de salvar vidas de la pandemia de COVID-19. Después de tres años, China tiene más recursos, mejores condiciones y más confianza para vencer a la covid”, indica el editorial.



Entre la ebullición tremenda de dos futbolistas únicos, extraordinarios, en una final de la Copa del Mundo trepidante, que sintió ganada dos veces Argentina, empatada por la fuerza increíble de Kylian Mbappe y decidida en la tanda de los penaltis, Lionel Messi por fin ganó su Mundial, traspasó aún más la eternidad, culminó una carrera sublime y devolvió a Argentina a la cima del fútbol por tercera ocasión en su historia, 36 años después de Maradona en México 1986, con una victoria agónica. En su quinta y última tentativa, dentro del relato maravilloso que ya describían sus regates, sus goles, sus pases, sus desbordes o su imponente palmarés en el Barcelona, incluyó el momento más único e icónico de todos, tan de -


seado desde Alemania 2006, tan ajeno en y Rusia 2018, tan frustrante en la final de lado de Di María, decisivo también, con un gol, en Qatar 2022. Su Mundial. No le falta A sus 35 años, ya es suyo. Ni siquiera cuando la Albiceleste conquistó su última do, al ritmo del genial Maradona, que parecía ble hasta que apareció Messi, que se ha rebelado la presión, ha soportado la responsabilidad nalizado todo para emocionar a un país entero, un equipo que lo complementó como nunca al césped la destreza técnica de Scaloni, seleccionador, a la altura este domingo de lardo. Palabras mayores. Mbappe lanzó el primero. Gol. Messi transformó
Francia no pudo emular a Brasil ganando dos títulos seguidos y le cedió el trono a Argentina. Lo hizo después de la que posiblemente sea la final más apasionante de la historia de la Copa del Mundo pero que no obvió que la campeona saliente acabó pagando su tardío despertar. Probablemente le pesó el llamado virus del camello que afectó a Rabiot y Upamecano pero que se dejó notar en otros jugadores. Le afectó ese virus, pero le arrasó la presentación albiceleste.
Hasta el punto de que despertó tan tarde que la justicia del fútbol no le quiso fallar a Messi, sonrió a Di María y entregó el papel de la eternidad al Dibu Martínez. Con una mención especial a Gonzalo Montiel, autor del penalti que le dio la oportunidad de volver a empatar en la prórroga a Mbappé, y anotador del
lanzamiento definitivo en la tanda de penalties.
Francia renació cuando estaba contra las cuerdas y volvió a hacerlo cuando se entendía imposible repetirlo, con la prórroga dirigiéndose a su conclusión y al límite chocó con el meta argentino para no poder consumar una remontada inaudita. Pero ya en la tanda definitiva no hubo una nueva oportunidad. Habría sido demasiado que tras errar dos lanzamientos pudiera llevarse el trofeo.
La campeona entregó la corona. Después de 79 minutos indignos para una campeona del Mundo se reengancho de la manera más inesperada a la pelea. Un penalti absurdo de Otamendi despertó a Mbappé y el despertar de la Bestia fue monumental, hasta el punto de tardar solo un minuto más para borrar su nefasta actuación hasta entonces, empatar el partido y convertir la final en una oda a la locura. Al sufrimiento, la pasión y la leyenda.
Argentina conquistó el título, como pudo hacerlo Francia, porque al final, en el fondo, existió la justicia que tantas veces se echa en falta en el fútbol. La albiceleste, liderada por un Leo Messi excelso y empujada por un Di María soberbio barrió a Francia durante toda una primera mitad en la que el equipo de Deschamps no remató ni una sola vez a puerta. Ni dentro ni fuera. Nada.
Desaparecido Mbappé, agarrotado Rabiot, invisible Griezmann, ausente Giroud y horroroso Dembélé, la campeona fue una sombra, atropellada por el ánimo, constancia y convencimiento de Argentina, que ya saltó al campo con una marcha más y en cuanto vio la deficiente puesta en escena gala se multiplicó. Ya fuera por el virus misterioso o por la rabiosa puesta en escena rival, lo cierto es que al equipo de Deschamps le costó una enormidad entrar en el partido.

Lionel Scaloni, entrenador na campeona del Mundial su alegría por haber de la Albiceleste en terior a la final ante “No estaba en mis do, pero lo somos fuimos justos vencedores”, de Pujato en la sala sail, donde sus dirigidos a Francia, luego de minutos.
Scaloni manifestó que que haberlo ganado prórroga”, pero destacó no darse por vencido Francia, de seguir tenía que dar”.
A continuación, todas el tercer entrenador * “Lo que yo vengo
Sudáfrica 2010
Brasil 2014 al un penalti y un falta nada.
había nacido Copa del Munparecía inigualarebelado contra responsabilidad y lo ha caentero, liderar a nunca y trasladar Scaloni, un magnífico de Menotti y Bi -
transformó el se -
gundo. El tercero de Coman lo paró ‘Dibu’ Martínez. El cuarto lo marcó Dybala. El quinto lo mandó fuera Tchouameni. El sexto lo anotó Paredes, el séptimo Kolo Muani y el octavo, el definitivo, Montiel para confirmar a Argentina como la campeona del Mundo. Y a Messi como un jugador aún más eterno.
Mereció ganar antes Argentina, que dinamitó de inicio el desafio. No dudó ni un segundo. Su convicción, su ambición, sin matices. Ninguno. No hay apenas nada al azar en la pizarra de Scaloni (salvo alguien como Mbappe). Huye de frases hechas, lo analiza todo, exhaustivo, lo comprime en una idea y lo expone sobre el terreno con unos futbolistas que lo ejecutaron con una determinación absoluta. Todo el primer tiempo. Hasta casi el final.

El exfutbolista brasileño Pelé, hospitalizado desde finales de noviembre, felicitó a Argentina por el título conquistado este domingo en un encuentro que calificó de “apasionante” y del que elogió las actuaciones de Leonel Messi y Kylian Mbappé en el partido definitorio del Mundial de Qatar.
“Felicitaciones Argentina, seguro que Diego está sonriendo ahora”, escribió el tres veces campeón mundial en Instagram.
En el mensaje, Edson Arantes do Nascimento hizo un reconocimiento a la trayectoria de Messi y aplaudió también el papel de Mbappé, la estrella de la Se -

entrenador de la Selección ArgentiMundial de Qatar 2022, expresó haber conseguido la tercera estrella en la conferencia de prensa posante Francia. mis planes ser campeón del muny lo más importante es la forma: vencedores”, sentenció el oriundo sala de prensa del Estadio de Ludirigidos vencieron en los penales de un dramático 3-3 en los 120

que “creía que el partido tendían ganado en los 90’ y después en la destacó “el espíritu del equipo de vencido cuando vinieron los goles de intentando sabiendo que se les
todas las frases de Lionel Scaloni, entrenador argentino campeón del mundo: diciendo en las ruedas de pren -
sa y que no voy a cambiar es que este equipo y estos jugadores juegan para la gente, juegan para el hincha argentino. Acá no hay ego, no hay individualidades, todos tiran para el mismo lado, es para el país. No hay orgullo más grande. Estos chicos se han brindado al máximo y han conseguido este título porque han entendido lo que hay que hacer adentro de la cancha. Estamos contentos, aunque la manera de salir campeón no es importante, yo creo que fuimos campeones merecidamente. Hicimos un partido completísimo y solo en contadas ocasiones nos metieron en aprietos”.
* “Festejar es lo primero que quiero. No quiero polémicas con los sudamericanos y europeos. Las selecciones sudamericanas son de primer nivel, por ahí se malinterpretaron las palabras de Mbappé, que de hecho juega con varios sudamericanos. Creo que es un tema zanjado y yo dije que por alguna cosa o la otra Sudamérica no tenía un título, pero que no era por el nivel. A veces tenés que eliminar a los mejores y podés quedar por el camino. A veces no hay que entrar en polémicas porque creo que no quiso decir eso”.
lección Francesa “@leomessi venciendo su primera Copa Mundial como era merecido por su trayectoria”, dijo la estrella del fútbol brasileño.
“Mi querido amigo @k.mbappe, marcando cuatro goles en una final. Qué regalo fue ver ese espectáculo”, agregó. Además, O Rei también hizo espacio para felicitar a la Selección de Marruecos por hacer “brillar” a África.
El tricampeón mundial, en tratamiento por un cáncer de colon, está ingresado desde el 29 de noviembre en el Hospital Albert Einstein de la ciudad de Sao Paulo, donde se recupera satisfactoriamente de una infección pulmonar, según el último boletín médico.
Según sus médicos, el exdelantero del Santos y Cosmos fue hospitalizado para evaluar un cambio en el tratamiento de quimioterapia al que se ha sometido desde que le extirparon un tumor en el colon, en septiembre de 2021.
Días más tarde, informaron que también padecía una infección respiratoria. La infección surgió después de que el exfutbolista contrajera covid-19 hace alrededor de un mes, según explicaron sus hijas.
Sus hijas también han desmentido versiones de prensa según las cuales Pelé ya no está respondiendo al tratamiento de quimioterapia, por lo que sus médicos optaron por suspenderlo y pasar a cuidados paliativos.
Con la satisfacción de la meta cumplida y cientos de juguetes listos para llegar muy pronto a las manos de niños y niñas de escasos recursos, se realizó con éxito la carrera pedestre “Corriendo con el Corazón, Regalamos más Sonrisas 5K”, organizada por el Voluntariado “Legislando con el Corazón”, del Honorable Congreso del Estado del Chiapas.
Tras dar el banderazo de salida al grito de “¡En sus marcas, listos, fuera!” por parte de la diputada Paola Villamonte Pérez, legisladores y funcionarios bajaron de la tarima y se sumaron a los cientos de corredores que con alegría corrieron sobre las principales calles de Tuxtla Gutiérrez, bajo un clima agradable y más que propicio para completar el trayecto de 5 kilómetros, cuya salida y meta es -
tuvo instalada frente al recinto legislativo.
En los resultados generales del evento atlético, los primeros tres lugares de la categoría Libre
Varonil fueron: 1° Jorge Guízar; 2° Rey Guízar y; 3° Francisco Villanzón. En la Libre Femenil el podio fue para: 1° Janet Escobar; 2° Monserrat Rincón y; 3°
Gabriela González. En la categoría para Discapacitados, los ganadores fueron: 1° Natan Morales; 2° Jhony Fredmann y 3° Samuel Ramos; por

el sector femenil los primeros lugares quedaron en poder de: 1° Gloria Gómez; 2° Lisette Astudillo y; 3° Fabiola Serrano. En Veteranos Varonil, los ganadores fueron: 1° Francisco Nava; 2° Arturo Marroquín y 3° Romeo Ramírez; por Femenil se alzaron triunfantes: 1° Eunice Kabuki Kiilu (Kenia); 2° Olga Escobar y; 3° Ernestina Ochoa. Y en la categoría Máster Varonil, los vencedores fueron: 1° Frank Vázquez; 2° Hugo Villanueva y; 3° Manuel Escobar; mientras que por el sector Femenil las ganadoras resultaron: 1° Mildred Melgar; 2° Brenda Mora y; 3° Janet Huesca. Adicionalmente se realizaron emotivas carreras infantiles de 100 metros, donde niñas y niños recibieron el aplauso de los corredores y porras de sus orgullosos padres, mientras que todos los inscritos fueron parte del sorteo para ganarse una bicicleta.
En seguimiento a los trabajos realizados en el marco de la conmemoración del Día Naranja 2022, este martes, la Comisión Nacional de Cultura Física y Deporte (CONADE), clausuró la campaña “¡ÚNETE! Activismo Deportivo para poner fin a la Violencia contra las Mujeres”, que tuvo una duración de 16 días y en los que se llevaron a cabo diferentes actividades.
La responsable de concluir esta estrategia fue la directora de Proyectos Especiales y encargada del Programa de Género en la CONADE, Mariana Limón Ramírez, quien agradeció el apoyo de todo el personal que labora en este organismo por compartir sus ideas y opiniones en la búsqueda de erradicar esta problemática social.
“Nos dimos a la tarea de hacer diferentes temáticas con la finalidad de identificar en la unidad administrativa cuál era la necesidad que detectaban para dar atención a la prevención de la violencia hacia las mujeres”, compartió.
Durante los 16 días de activismo deportivo, el área de Proyectos Especiales realizó diversas reuniones con los enlaces

de cada departamento de la CONADE, en las que se propusieron iniciativas, proyectos y actividades para aplicar entre los trabajadores y hacer conciencia sobre la violencia hacia las mujeres. Se dieron a conocer los compromisos establecidos en cada una de las mesas temáticas, así como las acciones que se realizarán durante el 2023 para sensibilizar a la comunidad del deporte sobre la importancia de prevenir la violencia hacia las mujeres en las políticas públicas de Cultura Física y Deporte. En esta campaña, también participó el Centro Paralímpico Mexicano (CEPAMEX) y el Centro Nacional de Desarrollo de Talentos Deportivos y Alto Rendimiento (CNAR), que a partir del siguiente año van a promover espacios de asesoría e información para identificar la violencia inmersa en el deporte.
Con la misión de subir al podio en los Juegos Centroamericanos y del Caribe San Salvador 2023 y los Juegos Panamericanos de Santiago 2023, el softbol mexicano llevará su preparación a Estados Unidos y Canadá, en donde buscará adquirir la mayor experiencia para enfrentar de la mejor manera sus compromisos del próximo año.
El presidente de la Federación Mexicana de Softbol, Rolando Guerrero, adelantó que se tomó esta decisión para que los combinados femenil y varonil lleguen a dichos eventos con un nivel competitivo acorde a lo que se enfrentarán en las justas.
Por ello, precisó, se asistirá, con equipos jóvenes, a la Liga Profesional de Softbol de Estados Unidos y acudirán a la Copa Canadá.
“En febrero y marzo estaremos en varios torneos en donde comenzaremos a definir el equipo que irá a los Centroamericanos en la rama femenil, en donde vamos por el podio, en este torneo, también en la varonil, vamos por el podio”, comentó en federativo en entrevista con la Comisión Nacional de Cultura Física y Deporte (CONADE).
Además de las competencias de ciclo olímpico que enfrentarán en 2023, el softbol nacional traza un ambicioso plan de trabajo que también busca destacar en el clasificatorio a la Copa del Mundo en la rama femenil.
“En la categoría Sub-15 se tiene el Panamericano en Perú, en abril, el cual es clasificatorio a la Copa del Mundo en Japón, en noviembre. Por eso es importante ya tener el programa para arrancar con buen camino a los objetivos”, expresó.

La pelota del cuadrangular número 62 de Aaron Judge, que batió el récord de la Liga Americana, se vendió por 1.5 millones de dólares, el sábado por la noche, a través de la firma de artículos coleccionables Goldin. Cory Youmans, quien atrapó la pelota en el Globe Life Field en Arlington, Texas, durante el juego del 4 de octubre entre los New York Yankees y los Texas Rangers, rechazó una oferta de 3 millones de dólares por la pelota y decidió subastarla.

Algunos creían que la famosa pelota desafiaría el récord de todos los tiempos pagado por una bola de beisbol, pero no alcanzó los 3.05 millones de dólares pagados por el jonrón de Mark McGwire, en 1998, por el dibujante de comics Todd McFarlane. La pelota del vuelacercas de Judge se exhibió en el J.P. Morgan Club en el Madison Square Garden el 7 de
diciembre, el mismo día que Judge firmó un contrato de nueve años y $360 millones para permanecer con Yankees. El contrato convirtió a Judge en el jugador de posición más caro en la historia de la MLB, con un valor anual promedio de 40 millones de dólares.
Youmans, vicepresidente de Fisher Investments, quien está casado con la reportera de Sports Illustrated, Bri Amaranthus, le dijo previamente a ESPN que esperaba que el lugar de permanencia final de la histórica pelota fuera con los Yankees o Cooperstown, pero que la subasta decidiría el final de la historia.
Judge dijo en noviembre, antes de firmar su contrato masivo, que no planeaba realizar ofertas por la pelota.
“Todavía no he firmado mi contrato de agente libre”, dijo Judge en ese momento. “Así que creo que está un poco fuera de mi rango de precios en este momento”.
Jalen Brunson anotó 30 puntos, Julius Randle sumó seis tiros libres en el último minuto y los Knicks de Nueva York superaron el domingo por 109-106 a los Pacers de Indiana para ligar siete victorias, la racha actual más larga en la NBA.

Hubo 19 cambios de ventaja y el último ocurrió a menos de un minuto del final cuando Randle atinó dos tiros de falta cuando quedaban 45,6 segundos para irse arriba 105-104. Después de que los equipos intercambiaron balones perdidos, Randle lanzó otros cuatro libres en las últimas dos posesiones. Los Pacers fallaron un tiro de casi media cancha en la bocina.Randle terminó con 25 tantos y 14 rebotes. RJ Barrett agregó 24 unidades. Brunson, que anotó 11 de 22 tiros de campo y tres triples, inició el regreso en el cuarto periodo con un triple tras estar abajo 104-98 y después robó el balón para un tiro de bandeja, todo en un lapso de 24 segundos.
Randle y Barrett han cargado con el equipo durante su racha de triunfos. Randle promedió 27 puntos, 11 rebotes y 4,2 asistencias en los seis duelos anteriores. Barrett 22 unidades y 6,8 tablas.
Jimmy Butler se adueñó de la Arena Ciudad de México en el partido que significó el regreso de la NBA a México. El 22 de Miami Heat, acom -
pañado por sus socios Bam Adebayo y Tyler Herro encaminaron al triunfo 111-101 contra San Antonio Spurs, donde destacó la actuación de Keldon Johnson, quien jugó con tenis tricolores mexicanos.
Desde antes de que diera inicio el partido, el inmueble ya estaba convertido en una sucursal más de Miami Heat, a pesar de que San Antonio Spurs era el local administrativo, por lo que Jimmy Butler fue el más ovacionado desde que se paró en la duela de la Ciudad de México, misma que fue invadida por el jersey 22 del alero del conjunto de Miami, que estaba por todos los pasillos del inmueble.
Stefanos Tsitsipas se consagró campeón del torneo de exhibición Mubadala WTC al vencer en la final por 6-2, 4-6 y 6-2 a Andrey Rublev. Ambos jugadores tuvieron un agitado 2022: el griego fue el jugador con más triunfos (61-24) y se quedó con 2 títulos mientras que el ruso cerró el año con 51-20 y cuatro trofeos. Ninguno de los dos jugará la semana próxima en la exhibición de World Tennis League (Emiratos Árabes Unidos). Tsitsipas volverá a tener actividad este año con la United Cup mientras que Rublev recién retomará el año que viene.
Por su parte, Casper Ruud se quedó con el tercer puesto del torneo de exhibición al derrotar 6-1 y 6-4 a Carlos Alcaraz (N°1 del mundo y quien le ganó
la final del US Open 2022).
El último torneo de exhibición del año será el World Tennis League (Emiratos Árabes Unidos), que tendrá a Iga Swiatek, Novak Djokovic, Caroline Garcia, Alex Zverev y Nick Kyrgios, entre otros. Otro cambio de cara en el equipo de Emma Raducanu y van...La británica anunció en Abu Dabi, donde participó de la exhibición Mubadala junto a Ons Jabeur, que le dio un retoque a su equipo de trabajo de cara a la próxima temporada.
El nuevo coach de la británica será Sebastian Sachs, un hombre con experiencia al más alto nivel en el circuito femenino ya que por sus entrenamientos pasaron nombres como los de Victoria Azarenka, Julia Görges y Belinda Bencic, quien obtuvo el Oro olímpico en Tokio bajo su mandato.

Y promesa del futbol español es Athenea del Castillo, que juega para su selección y el Real Madrid por el momento y ya figura.


El británico Ross Brawn dejó su cargo directivo dentro de la organización de la Fórmula 1, tal y como anunció desde la temporada 2021, cuando señaló que 2022 sería su último año en el serial.
“Amó todo lo que he hecho en los últimos años”, señaló Ross Brawn en lo que sería su última colaboración editorial para F1.com –el ingeniero británico desde 2017 tomó un puesto directivo dentro de la categoría una vez fue tomada por el grupo de Liberty Media.

“He sido muy afortunado de que Liberty me haya dado la oportunidad y fue un trabajo de amor”. “Ahora es el momento ade -
cuado para que me retire. Hemos hecho la mayor parte del trabajo y ahora estamos en un período de consolidación. Llegará un auto nuevo en 2026, pero faltan cuatro años, bastante lejos para mí, por lo que es mejor que el próximo grupo de personas asuma ese manto. Creo que estoy dejando la F1 en un gran lugar”, reflexionó Ross Brawn, uno de los grandes artificies de la dinastía Schumacher-Ferrari, de 1999 (cuando el equipo ganó el campeonato de constructores) a 2004 (último campeonato consecutivo de Michael Schumacher y de Ferrari, que volverían a ser campeones de equipos en 2007 y 2008, ya sin Schumi y Brawn a bordo).
“He disfrutado casi cada minuto de mi carrera de 46 años y he tenido la suerte de haber trabajado con muchos grandes equipos, grandes pilotos y grandes personas, no cambiaría nada. Una certeza es que, sin el apoyo de mi esposa y mi familia no
podría haberlo hecho, y no hubiera querido hacerlo”.
“Ahora veré la F1 desde mi sofá, animando y maldiciendo como fanático de la F1, complacido de que el deporte esté en un lugar fantástico y tenga un futuro tan fantástico”.

La fiesta terminó y con ella, comienza la nostalgia del largo tiempo que hay que esperar para tener un mes como el que recién coronó a Argentina campeón, terminando el dominio europeo que concluyó rindiéndose ante quien consideran el mejor jugador de la actualidad. Pero no podemos dejar pasa que fue una justa atípica demás, con aficionados “rentados” de inicio, para presumir una fiesta que no terminó por cuajar en la tribuna, igual no hacía falta, porque a la sede lo económico no le duele. Qatar buscó un evento para continuar construyendo una historia, carente de loas, de hazañas, de revoluciones y todo lo que presumen en otros lados.
Será el mundial de las ausencias y podemos hablar de selecciones que no clasificaron, pero debemos hacerlo de las que sí y vieron a figuras y referentes, luchar con un calendario anormal; ahora, hay que volver a las competiciones a ver quién puede recuperarse mejor y ayudar a su equipo. No basta con continuar construyendo argumentos para erigir a Messi como el mejor de la historia, seguirá siendo una polémica lejana y dispareja; sin embargo, el argentino debe ser el más agradecido por haberse encontrado a la combinación de factores, partiendo de un entrenador que entró de interino y ahora se meterá en la historia por romper la sequía de 36 años y que es quien inspiró el término “Scaloneta”, cuando se hablaba en Argentina del divisionismo que siempre existe en el futbol; ahora, debe ser ubicado entre los más grandes de la historia y comenzar a trabajar en otro problema serio, la vida sin Messi.
Hay que hablar también del grupo que se armó en Argentina, quienes entendieron que Messi no era suficiente y había que ayudarle a conseguir el objetivo, además, el factor fortuna, que se había echado en contra, ahora le sonrió.
Se acabó el mundial, pero no la polémica, Argentina se lleva la copa a casa y comienza la cuenta regresiva para otra justa que promete ser más atípica todavía.
Lunes 19 de diciembre de 2022
www.sie7edechiapas.com
Tuxtla.- Un autotanque que transportaba gas LP y propiedad de una empresa privada terminó volcando sobre la carpeta asfáltica sobre la carretera a La Angostura a la altura de Ribera de Cupía y justo a unos metros del retén de la Secretaría de Seguridad y Protección Ciudadana ( SSyPC) del municipio de Chiapa de Corzo.



De acuerdo con datos recabados, el reporte fue proporcionado alrededor de las 10:10 horas, cuando la pesada unidad sufrió un daño mecánico que lo hizo volcar sobre la carpeta asfáltica.
Elementos de la Guardia Nacional solicitó el apoyo inmediato del personal del Heroico Cuerpo de Bomberos para enfriar la cisterna del vehículo pues contenía gas LP.
Tras varios minutos de intensos trabajos, los tragahumos finalmente controlaron todo riesgo además de, eliminar las fugas de aceite y combustible.
Por su parte, los oficiales de la Guardia Nacional solicitaron el apoyo de una grúa con plataforma y otra de ancla para remolcar el camión cisterna y así liberar finalmente la vialidad en ambos carriles que comunican al aeropuerto internacional Ángel Albino Corzo.
Tuxtla.- Un joven de 28 años resolvió quitarse la vida por ahorcamiento dentro de su habitación, durante la mañana de ayer en la colonia Patria Nueva. De acuerdo con datos obtenidos, el hecho fue registrado alrededor de las 08:10 horas, cuando elementos policiales municipales y estatales arribaron a la avenida Nogal, entre las calles Avellano y Abedul de la referida colonia.

Los oficiales, solicitaron de forma inmediata el apoyo de una unidad de emergencias pues un joven se había ahorcado con el apoyo de una soga asegurada al marco de la ventana de su cuarto.
En minutos, se constituyeron paramédicos de la Cruz Roja Mexicana, los cuales, le brindaron la atención prehospitalaria a Manuel Alejandro “N”, de 28.
La escuadra de socorristas señalaron que, la persona ya no contaba con signos vitales.
En este sentido, Carlos Alberto “N” de 27, fue entrevistado por
las fuerzas del orden y manifestó ser familiar del ahora occiso.
En este sentido, manifestó que, la noche del sábado, Manuel
estuvo consumiendo bebidas embriagantes, sin embargo, su familia se fue a dormir y dejaron solo al masculino.

 COMUNICADO · EL SIE7E
COMUNICADO · EL SIE7E
SCLC.- Dos jóvenes cayeron de una motocicleta, tras chocar contra un vehículo Nissan tsuru, en su modalidad de taxi, tras circular entre el boulevard Los Cronistas y avenida Veterinarios de la Colonia Prudencio Moscoso en la zona norte de San Cristóbal.

De acuerdo a los afectados, el taxista quien circulaba con aliento alcohólico estaba dando vuelta hacia la avenida Veterinarios, pero por la velocidad ambos no pudieron frenar y se impactaron, lo que ocasionó que los jóvenes cayeran de la motocicleta.
Afortunadamente solo fueron daños materiales
y golpes leves.
El propietario del taxi, llegó a buenos términos con el dueño de la motocicleta, por lo que no fue necesario llamar a los elementos de tránsito municipal.

Tuxtla.- La Fiscalía General del Estado (FGE), a través de la Fiscalía de Distrito Centro, investiga el Homicidio cometido en agravio de dos personas del sexo masculino, en el municipio de Berriozábal, Chiapas.

Luego de conocer la noticia criminal, personal de la Policía de Investigación y de Servicios Periciales acudió a la colonia Celia Herrera, municipio de Berriozá -
bal. En el lugar de los hechos se encontraron dos cuerpos sin vida, de personas del sexo masculino, no identificadas.
Los cuerpos presentaban impactos de arma de fuego. En el lugar se encontraron casquillos percutidos de diversos calibres. Se iniciaron con las primeras diligencias e investigaciones que permitan esclarecer el doble homicidio. Los cadáveres fueron trasladados al Semefo para la necropsia de ley.
Tuxtla. La Fiscalía General del Estado (FGE) a través de la Fiscalía de Distrito Istmo Costa, reintegró al seno familiar a un adolescente con reporte de no localizado en el municipio de Tonalá, Chiapas.

Alejandra “N” compareció ante esta Fiscalía para reportar que su sobrino de iniciales C.E.R.P de 13 años de edad, había desaparecido de su domicilio el día 15 de diciembre del año 2022. Se inició el registro de atención y conforme al protocolo en la materia, se giraron oficios de búsqueda y localización a todas las autoridades.
Hoy, a través de trabajos de inteligencia y con el apoyo de los familiares de la víctima, elementos de la Policía de Investigación localizaron al adolescente de iniciales C.E.R.P, sano y salvo en Ojo de Agua, municipio de Tonalá, Chiapas.
Fue escuchado en declaración ministerial, asistido por un gru -
po multidisciplinario. Tras corroborarse que se encontraba en buenas condiciones de salud y que no había sido víctima de algún delito, el adolescente fue reintegrado al seno familiar. Alejandra “N” reconoció la oportuna respuesta de la Fiscalía General del Estado al localizar sano y salvo a su sobrino.

Redacción Ciencia.- Las extinciones en cascada de especies son inevitables. Un nuevo estudio, basado en modelos, señala que la Tierra perderá una media de hasta el 10 % de sus animales y plantas para 2050 debido al uso del suelo y el cambio climático.
Esa pérdida media de biodiversidad podría llegar hasta el 27 % en 2100, según señala el trabajo que publica hoy Science Advances en el que han colaborado científicos europeos y australianos.
El estudio se centra en las extinciones en cascada o coextinción. Cuando una especie se pierde directamente por una perturbación (extinción primaria), puede haber otra que sea depredadora de la primera que también desaparecerá porque se queda sin alimento.
En el caso de las plantas, si pierde a sus insectos polinizadores porque hace demasiado calor también sucumbirá, pues todas las especies dependen de alguna manera de otras.
Los autores advierten de que los planteamientos considerados hasta ahora para evaluar las trayectorias de extinción
durante el próximo siglo se han visto obstaculizados por no incorporar las coextinciones.
Así desarrollaron una nueva herramienta para modelizar la pérdida interconectada de especies usando los superordenadores más potentes de Europa, con el objetivo de predecir el destino conectado de especies que probablemente desaparecerán por los estragos del cambio climático y del uso del suelo.
La herramienta “presenta una sombría predicción del futuro de la diversidad global, confirmando sin lugar a dudas que el mundo se encuentra inmerso en su sexto evento de extinción masiva”, según la Universidad de Flinders (Australia)
El equipo creó una gran Tierra virtual de redes de especies interconectadas, vinculadas por quién come a quién, y luego aplicaron cambios climáticos y de uso del suelo al sistema para lograr proyecciones de futuro.
Las especies virtuales también podrían volver a colonizar nuevas regiones al cambiar el clima, adaptarse en cierta medida a las condiciones cambiantes, extinguirse directamente a causa del cambio global o ser víctimas de una cascada de extinciones.
“Esencialmente, hemos poblado
un mundo virtual desde cero y cartografiado el destino resultante de miles de especies de todo el planeta para determinar la probabilidad de que se produzcan puntos de inflexión en el mundo real”, explicó Giovanni Strona del Centro Común de Investigación de la Comisión Europea.
De esta forma, pudieron evaluar la adaptación a distintos esce -
narios climáticos y relacionarla con otros factores para predecir un patrón de coextinciones.
Este estudio es único porque también tiene en cuenta el efecto secundario sobre la biodiversidad, estimando el efecto de la extinción de especies en las redes alimentarias locales más allá de los efectos directos -extinción primaria-.
“Los niños nacidos hoy que vi -
van hasta los 70 años pueden presenciar la desaparición de miles de especies vegetales y animales, desde las orquídeas más diminutas y los insectos más pequeños hasta animales emblemáticos como el elefante y el koala, todo ello a lo largo de una vida humana”, advirtió Corey Bradshaw de la Universidad de Flinders, uno de los firmantes.

Redacción Ciencia.- Los cambios en el clima mundial junto a la extinción masiva sufrida durante el Triásico-Jurásico, que acabó con muchos vertebrados de gran tamaño, fueron circunstancias que beneficiaron el ascenso de los primeros dinosaurios.
Los dinosaurios tipo saurópodos, que se convirtieron en las especies herbívoras gigantes de finales del Jurásico, como el Diplodocus y el Brachiosaurus, pudieron prosperar y expandirse por nuevos territorios a medida que el planeta se calentaba tras la extinción, hace 201 millones de años.
Las nuevas pruebas las aporta un estudio realizado por científicos británicos, brasileños y alemanes, basado en modelos matemáticos que publica Current Biology
El equipo comparó modelos informáticos de las condiciones climáticas globales prehistóricas, como la temperatura y las precipitaciones, con datos sobre las distintas ubicaciones de los dinosaurios extraídos de fuentes como la Base de Datos de Paleobiología.
Con estos datos demostraron que los saurópodos y animales similares, con sus largas colas y cuellos y sus pequeñas cabezas, fueron el éxito arrollador de un turbulento periodo evolutivo, explicó la Universidad de Birmingham (Reino Unido), una de las firmantes.
“Lo que vemos en los datos sugiere que, en lugar de que los dinosaurios fueran superados por otros grandes vertebrados, fueron las variaciones en las condiciones climáticas las que restringieron su diversidad. Pero una
vez que estas condiciones cambiaron en el límite entre el Triásico y el Jurásico, pudieron prosperar”, indicó una de las investigadoras, Emma Dunne.
Estos resultados fueron “algo sorprendentes” para el equipo porque, destacó Dunne, los saurópodos eran “realmente exigentes desde el principio: más adelante en su evolución siguen permaneciendo en zonas más cálidas y evitan las regiones polares”.
El coautor del trabajo Richard Butler, de la misma universidad, destacó que “el cambio climático parece haber sido realmente importante para impulsar la evolución de los primeros dinosaurios”.
El equipo prevé ahora utilizar las mismas técnicas para comprender el papel del clima en los siguientes 120 millones de años de la historia de los dinosaurios.

CDMX.- Las bacterias de la lepra pueden tener el secreto para reparar y regenerar el cuerpo de manera segura, dicen investigadores de la Universidad de Edimburgo.
Los experimentos con animales han revelado la notable capacidad de la bacteria para casi duplicar el tamaño de los hígados con un crecimiento saludable. Es un acto furtivamente egoísta que le da a la bacteria más tejido para infectar. Pero descubrir cómo lo hacen podría conducir a nuevas terapias que desafíen la edad, dicen los científicos.

La lepra causa invalidez cuando infecta los nervios, la piel y los ojos.
A lo largo de la historia, los infectados han sido repudiados y aislados de la sociedad.
Pero la bacteria que lo causa, Mycobacterium leprae, tiene otras propiedades inusuales, incluida la capacidad de realizar «alquimia biológica», convirtiendo un tipo de tejido corporal en otro.
Una habilidad que fascina a los científicos.
Así que para estudiarla los investigadores recurrieron al otro animal que, como la especir humana, puede contraer la enfermedad: los armadillos.
Los experimentos, que se realizaron en Estados Unidos, mostraron que la
infección se dirige a los hígados de los armadillos.
Allí la bacteria realiza un secuestro controlado del órgano para reprogramarlo para su propio propósito.
«Fue totalmente inesperado», me dijo el profesor Anura Rambukkana, del centro de medicina regenerativa de la Universidad de Edimburgo.
Los resultados, publicados en Cell Reports Medicine, mostraron que el tamaño del hígado casi se duplicó.
Se podría esperar que dicho crecimiento fuera defectuoso o incluso canceroso, pero un análisis detallado mostró que el órgano era saludable y funcional, y que tenía la disposición habitual de vasos sanguíneos y conductos biliares.
«Es un poco alucinante», dijo el profesor Rambukkana. «¿Cómo hacen eso? No hay terapia celular que puedahacer eso».
Parece que la lepra rebobina el reloj del desarrollo en el hígado.
Las células hepáticas completamente desarrolladas son potencias metabólicas que tienen cientos de trabajos distintos que llevar a cabo en el cuerpo.
Pero las bacterias los están llevando de regreso a una etapa anterior, como volver a ser adolescentes, donde pueden aumentar rápidamente en número antes de volver a la edad adulta.
Al investigar la actividad de diferentes partes del ADN de las células, los cien-
tíficos descubrieron una imagen más parecida a la de un animal mucho más joven o incluso un feto, cuando el hígado aún se está formando.
“Proceso natural”
Pero los detalles precisos de cómo sucede todo esto siguen siendo esquivos.
La investigación ganadora del Premio Nobel ha demostrado que es posible hacer retroceder a la fuerza el reloj hasta el punto en que las células recuperan la capacidad de convertirse en cualquier otro tipo de célula en el cuerpo, pero esto conlleva el riesgo de convertir esas células en cancerosas.
«Las bacterias [de la lepra] usan vías alternativas», me dijo el profesor Rambukkana.
«Es una forma mucho más segura y tardan más tiempo en hacerlo, por lo que es un proceso natural».
“Resultados prometedores”
La esperanza es que el enfoque pueda aprovecharse para reparar los hígados de las personas que esperan un trasplante, o incluso para revertir algunos de los daños causados por el envejecimiento en otras partes del cuerpo.
«El sueño es usar la misma estrategia bacteriana, usar el ingenio de las bacterias para generar nuevos medicamentos para la regeneración y reparación», dijo el profesor Rambukkana. «Si puedes aprovechar eso, deberías poder convertir ese mecanismo en un pinchazo que tienes cada tres meses o algo así».
Sin embargo, todas estas ideas siguen sin probarse.
El doctor Darius Widera, de la Universidad de Reading, dijo: «En general, los resultados podrían allanar el camino para nuevos enfoques terapéuticos para el tratamiento de enfermedades hepáticas como la cirrosis».
«Sin embargo, dado que la investigación se ha realizado utilizando armadillos como animales modelo, no está claro si estos resultados prometedores se pueden llevar a la biología del hígado humano y cómo se puede hacerlo», añadió. «Además, dado que las bacterias utilizadas en este estudio causan enfermedades, se requeriría un refinamiento sustancial de los métodos antes de la llevarlos a ensayos clínicos».
CDMX.- Playa Balandra es quizás una de las playas más emblemáticas del municipio de La Paz, Baja California Sur, por su blanca arena y la claridad de sus aguas. No obstante, pocas personas conocen que ese sitio es parte del Área de Protección de Flora y Fauna Balandra, un área natural federal administrada por la Comisión Nacional de Áreas Naturales Protegidas (CONANP). En esta zona de aproximadamente 2,250 hectáreas viven cientos de plantas y animales (terrestres y marinos) que residen en las formaciones coralinas, las dunas, los manglares o en el matorral xerófilo que la rodea. Lo más interesante es que algunas de estas plantas y animales son únicas en el mundo y solo viven en esa localidad.
Recientemente, investigadores del Centro de Investigaciones Biológicas del Noroeste, S. C. (Unidad La Paz) describieron dos especies nuevas para la ciencia, una araña tejedora y una planta con flores, ambas procedentes de este emblemático lugar.
La araña fue descubierta por el equipo liderado por la doctora María Luisa Jiménez, en colaboración con el maestro Carlos Palacios y el doctor David Chamé. Primeramente, el maestro Carlos fotografió una peculiar araña pequeña que construye redes entre las piedras, y adorna su refugio prin-
cipalmente con arena. Las fotografías condujeron al estudio de esta enigmática araña que pertenece a la familia Diguetidae, un grupo de arañas que viven, sobre todo, en las zonas semiáridas y áridas de Norteamérica. La araña fue nombrada como Diguetia balandra y parece que solo habita en dicha región.
Este hallazgo fue publicado en la prestigiosa revista Zootaxa y en el mismo estudio se incluyó más información sobre otras especies de Diguetidae de la península de Baja California. Curiosamente, esta especie es la novena que se encuentra en México de un total de 11 especies de Diguetia conocidas en el mundo; además, es la segunda especie descrita, tan solo en este año por el grupo anteriormente mencionado, quienes continúan estudiando a las arañas que moran las múltiples playas y serranías
de la entidad.
En cuanto a la nueva especie de planta, fue descubierta en las colinas del Área de Protección de Flora y Fauna Balandra al inicio de la pandemia de covid-19 (en enero de 2020); y gracias a la abundante lluvia que tuvimos en ese invierno, integrantes del Herbario del Cibnor advirtieron una planta semiarbustiva, singular, en las colinas que rodean Balandra.
Aunque esta planta ya había sido colectada desde hacía algunos años, fue hasta que sus estados fenológicos (flores, semillas) permitieron concluir que se trataba de una especie aun no descrita para la flora mundial.
Coincidentemente, en esos mismos días en el sitio estuvo de exploración el entonces estudiante de la Universidad de California (Berkeley) Isaac
Lichter-Marck, quien realizaba su investigación doctoral sobre filogenia de un grupo de plantas de la familia Asteraceae, la misma a quien pertenece nuestra planta referida. Isaac también advirtió la planta y, en una plática con el equipo de investigación, se confirmó que se trataba de una especie nueva perteneciente al género Encelia, y que había que publicar este hallazgo de manera conjunta.
La descripción de una nueva especie, a la que se decidió llamar Encelia balandra (por el sitio donde se encontró), requirió de investigación para describirla morfológicamente en detalle, así como compararla con especies afines de su misma familia y género, con el fin de encontrar las diferencias y singularidades.
Lo relevante de este hecho es que en dichas colinas se encuentran algunas especies de plantas que parecen restringirse en su distribución en la zona de Pichilingue-Balandra-El Tecolote, como lo son una especie de “viejito” (Mammillaria arida), un “palo adán” de flores rosadas (Fouquieria burrageana), una acacia (Acacia pacensis) y una variedad de “chamizo” (Atriplex canescens var. macropoda), hechos que representan valiosos argumentos para insistir en la conservación de la biodiversidad de la región, la cual actualmente soporta fuertes amenazas ante la expansión del desarrollo de la Ciudad de La Paz.

Tuxtla.- Con la satisfacción de la meta cumplida y cientos de juguetes listos para llegar muy pronto a las manos de niños y niñas de escasos recursos, se realizó con éxito la carrera pedestre “Corriendo con el Corazón, Regalamos más Sonrisas 5K”, organizada por el Voluntariado “Legislando con el Corazón”, del Honorable Congreso del Estado del Chiapas.
Minutos antes de las 7:00 de la mañana y previo al banderazo de salida, se realizó el protocolo inaugural, encabezado por la Diputada Paola Villamonte Pérez, presidenta del Voluntariado “Legislando con el Corazón”, en compañía de Tania Robles Velázquez, directora general del Instituto del Deporte (Indeporte), en representación del Gobernador Constitucional del Estado de Chiapas, Rutilio Escandón Cadenas, así como el Diputado, Aarón Yamil Melgar Bravo, presidente de la Junta de Coordinación Política del H. Congreso del Estado, y como invitados especiales: Delia María González Flandes, Director General del Sistema DIF Chiapas, Ángel Torres Culebro, Secretario de Obras Públicas, Adriana Margarita López Sánchez, Coordinadora del Voluntariado de Corazón del Sistema DIF Chiapas, Magaly Chávez Guillén, directora de Incubadora Chiapas y Conrado Cifuentes Astudillo,
presidente del Comité Ejecutivo Estatal del Partido Chiapas Unido.
Tras dar el banderazo de salida al grito de “¡En sus marcas, listos, fuera!” por parte de la diputada Paola Villamonte Pérez, legisladores y funcionarios bajaron de la tarima y se sumaron a los cientos de corredores que con alegría corrieron sobre las principales calles de Tuxtla Gutiérrez, bajo un clima agradable y más que propicio para completar el trayecto de 5 kilómetros, cuya salida y meta estuvo instalada frente al recinto legislativo.
En los resultados generales del evento atlético, los primeros tres lugares de la cate-
goría Libre Varonil fueron: 1° Jorge Guízar; 2° Rey Guízar y; 3° Francisco Villanzón. En la Libre Femenil el podio fue para: 1° Janet Escobar; 2° Monserrat Rincón y; 3° Gabriela González.
En la categoría para Discapacitados, los ganadores fueron: 1° Natan Morales; 2° Jhony Fredmann y 3° Samuel Ramos; por el sector femenil los primeros lugares quedaron en poder de: 1° Gloria Gómez; 2° Lisette Astudillo y; 3° Fabiola Serrano.
En Veteranos Varonil, los ganadores fueron: 1° Francisco Nava; 2° Arturo Marroquín y 3° Romeo Ramírez; por Femenil se alzaron triunfantes: 1° Eunice Kabuki Kiilu (Kenia);
2° Olga Escobar y; 3° Ernestina Ochoa. Y en la categoría Máster Varonil, los vencedores fueron: 1° Frank Vázquez; 2° Hugo Villanueva y; 3° Manuel Escobar; mientras que por el sector Femenil las ganadoras resultaron: 1° Mildred Melgar; 2° Brenda Mora y; 3° Janet Huesca.
Adicionalmente se realizaron emotivas carreras infantiles de 100 metros, donde niñas y niños recibieron el aplauso de los corredores y porras de sus orgullosos padres, mientras que todos los inscritos fueron parte del sorteo para ganarse una bicicleta.
Antes de poner la guinda a la carrera “Corriendo con el Corazón, Regalamos más Sonrisas 5KM” y previo la ceremonia de premiación final para los triunfadores, el diputado Aarón Yamil Melgar Bravo, presidente de la Junta de Coordinación Política del H. Congreso del Estado y Vocal del Voluntariado “Legislando con el Corazón”, agradeció a todos quienes se sumaron a este esfuerzo para llevar alegría a niños y niñas en situación vulnerable, al tiempo que invitó a la sociedad chiapaneca a seguir haciendo deporte, pues es la forma más efectiva de prevenir enfermedades crónico-degenerativas.
“No lo dejen de hacer, sigan practicando el ejercicio y muchas gracias por estar aquí, en este domingo tan espléndido”, concluyó entre los aplausos de los presentes.


Tuxtla.- Más de cuatro mil personas, recibieron en Tapachula al Diputado Federal Ismael Brito Mazariegos, en el marco de los diálogos para seguir Impulsando el Bienestar y la mejora de Chiapas, con los que desde hace algunos meses, recorre el estado para escuchar a la ciudadanía. El encuentro multitudinario, se

realizó en las instalaciones de la Asociación Ganadera Local, en donde miles de personas lo recibieron con porras, pancartas y banderas.
En su intervención, Brito Mazariegos resaltó la importancia de escuchar a la ciudadanía para ser fiel intérprete de lo que la gente necesita y destacó: “este recorrido por todo el estado, está siendo fundamental para el desarrollo de
trabajos legislativos que benefician a los chiapanecos”.
Aseguró también que estos ejercicios, son su aportación al gran esfuerzo que se realiza en conjunto en favor de la cuarta transformación. “Vengo al Soconusco a sumarme al gran trabajo del Gobernador Rutilio Escandón que sé que muy seguido está por aquí y quiero que estos diálogos sirvan para fortalecer a la cuar-
ta transformación del país y de Chiapas”.
Durante el evento, se proyectaron audiovisuales relativos a los logos parlamentarios del Diputado Federal, en los que se detallaron los beneficios de la Ley del Café que presentó en San Lázaro, así como el punto de acuerdo que propuso y que fue aprobado por el pleno de la Cámara de Diputados, en relación a la reactivación
de la tarjeta de visitante regional que permite la llegada de visitantes guatemaltecos que activan la economía.
Brito Mazariegos ha encabezado estos diálogos también en: Tonalá, Chiapa de Corzo, Simojovel, Bochil, Rayón, Jaltenango, Amatenango, San Cristóbal y Tuxtla, en donde ha hablado con miles y ha recibido el respaldo de importantes liderazgos políticos.
SCLC.- Integrante de la Sociedad Civil Las Abejas denunciaron que les cortaron el agua y la energía eléctrica, por lo que en un escrito exigen se restablezcan ambos servicios de lo contrario verán con sus propios recursos cómo solucionan el problema.
En el comunicado aseguran que esto forma parte de la persecución y hostigamiento que han sido víctimas desde hace 25 años. Narran que el
pasado 15 de diciembre a la familia Pérez Pérez, que pertenecen a Las Abejas, les fue suspendido el servicio.
“Esto fue realizado por los partidistas acompañados de su agente y patronatos de la comunidad Campo Los Toros, municipio de Chenalhó, esta violencia en contra de la familia se debe a que le compartía el uso de electricidad a Juvencio Pérez Solís, miembro de la familia quien ya vive en otro hogar y que les habían cortado los mismos servicios junto a 4
familias más desde el 8 de febrero del 2021, es así que los miembros de la organización siguen siendo maltratados”, dicta el escrito. Por lo anterior, exigen a las autoridades restablecer todos los servicios a sus compañeros, ya que el presidente de Chenalhó ha hecho caso omiso las denuncias de las familias afectadas, además, el Centro Derecho Humanos Fray Bartolomé de las Casas (Frayba), ya notificó a las autoridades en los tres niveles de gobierno para su conocimiento.

Tuxtla.- Chiapas reporta 11 casos nuevos de COVID-19 en las últimas horas, de ellos cuatro en Tuxtla Gutiérrez, tres Pichucalco, así como uno en Ángel Albino Corzo, Reforma, Tapachula y Yajalón; no se reportaron fallecimientos por esta enfermedad.
La dependencia estatal informó que los casos positivos se presentaron en seis mujeres y cinco hombres, con edades de
25 a 65 años y más, de ellos cuatro pacientes sufren de hipertensión arterial, inmunosupresión, diabetes mellitus y tabaquismo.
La Secretaría de Salud del estado exhorta a los chiapanecos y chiapanecas que además de mantener las medidas sanitarias es importante que acudan a su unidad más cercana para colocarse la vacuna de influenza, ya que es una de las enfermedades más comunes en esta época invernal.


ciones previas sobre Archaeolemur, en particular con la evidencia de que sus dientes frontales grandes y robustos pueden haber sido utilizados para procesar una dieta que contenía alimentos duros.
Towle cree que el estudio plantea la «posibilidad fascinante» de que las herramientas de piedra no explican necesariamente la alta tasa de fracturas en los dientes de los neandertales.
«Archaeolemur muestra patrones simi-
lares de astillado de dientes, pero no hay evidencia que sugiera que fueran capaces de usar tales herramientas. Estudiar primates extintos no solo proporciona información crucial sobre su dieta y comportamiento, sino que también aclara nuestra propia historia evolutiva».
Dada la superposición en la forma del cráneo y los dientes, y las posibles similitudes en la dieta y el comportamiento, tal
vez no sea sorprendente que se pensara que Archaeolemur era un simio cuando se descubrió por primera vez en Madagascar hace más de 100 años.
«Archaeolemur es un brillante ejemplo de evolución convergente, que muestra notables similitudes con los monos y simios.
Esta especie también destaca hasta qué punto los lémures de Madagascar se diversificaron en una variedad de nichos ecológicos».
CDMX.- El análisis de los dientes de lémures extintos ha revelado pistas fascinantes sobre la evolución de los humanos, con similitudes fascinantes, según un estudio de la Universidad de Otago.
El autor principal, el doctor Ian Towle, del Instituto de Investigación Sir John Walsh en la Facultad de Odontología, dice que el lémur mono «sorprendentemente grande», Archaeolemur, tenía características anatómicas novedosas que no se ven en los lémures vivos, como la falta de un «peine de dientes» en la parte delantera de la boca para acicalarse.
«Estos lémures extintos son muy diferentes a los que viven hoy. También muestran similitudes fascinantes con los monos y simios, incluidos los humanos», dice en un comunicado.
El estudio, publicado en el American Journal of Biological Anthropology, tuvo como objetivo evaluar la dieta de Archaeolemur
analizando el astillado en 447 dientes, comparando las frecuencias de astillado con las de otros primates.
Los resultados fueron sorprendentes: con estos notables lémures extintos con dentición que se asemejan a los babuinos en forma; pero presentando patrones de astillado de dientes similares a los homínidos fósiles como los neandertales.
«Los patrones de astillado de dientes de Archaeolemur son diferentes a cualquier primate vivo, con sus dientes frontales mostrando fracturas sustanciales, a menudo con numerosas astillas de dientes en un solo diente, pero muy pocas astillas en sus dientes posteriores.
«Se observan patrones de fractura de dientes similares en homínidos fósiles, como los neandertales. Por lo general, en los neandertales se cree que estos patrones de fractura están relacionados con los comportamientos de uso de herramientas», dice Towle.
Los resultados coinciden con investiga-


Rosario.- El caos en Rosario, la ciudad donde nació Leo Messi, es absoluto. Miles de personas atiborraron las calles de la ciudad para festejar que su hijo más ilustre es desde hoy más planetario si cabe tras ganar la Copa del Mundo con la Albiceleste, sin olvidar a su otro orgullo, Ángel Di María.

Como si no hubiera un mañana, el entorno del Monumento Nacional a la Bandera, centro neurálgico de celebraciones de la localidad, ubicada a orillas del río Paraná y a 300 kilómetros al norte de Buenos Aires, acabó, nunca mejor dicho, hasta la bandera: una masa de jóvenes, padres, niños y abuelos se congregaron en una fiesta que quedará para siempre en sus memorias.
“Messi, jugá hasta los 95 como Mirtha Legrand”, rezaba el cartel que varias amigas portaron orgullosas para pedir al astro que recapacite y no descarte jugar un Mundial más y seguir adelante con su carrera, tenga la edad que tenga, haciendo un paralelismo con la más veterana
diva de la televisión argentina.
“Nadie quiere que se vaya ahora, que siga y juegue unos cuantos mundiales”, señaló a EFE Valentina junto a la pancarta, e invitó a Leo a que vuelva a su ciudad y se incorpore a uno de los dos equipos más importantes de Rosario, el Newell’s Old Boys, en el que de muy pequeño formó parte de su cantera, antes de irse en el año 2000 a Barcelona.
Acompañado de varios amigos, Esteban también animó a ‘la Pulga’: “Te lo merecés hermano, gracias por todo, y te esperamos acá en Newell’s, papá, tenes que venir, esta es tu casa. Tenés que jugar, tenés que seguir jugando cuatro años más, Lío, sos el mejor del mundo”. Sin embargo, otro hincha, Mauro, se mostró convencido de que Messi debe terminar su carrera “donde él quiera, que sea feliz”, y se refirió además a la posibilidad de que este haya sido su último Mundial: “Para mí era el último, pero ahora que lo ganó no sé, uno más puede jugar”. Hinchas con y sin camiseta -el verano está a punto de llegar a Argentina-, unos
subidos a los semáforos, otros a las estatuas, con y sin voz tras horas de gritos y nervios. Mamás y papás cargando bebés en medio de la multitud, o abuelos y abuelas rejuveneciendo años gracias al enorme logro de la ‘Scaloneta’. Todos ellos y muchos más se agolparon en las calles rosarinas tras la victoria final de la Albiceleste en Qatar ante la selección francesa: “Es una alegría inmensa, porque era lo que queríamos por él (Messi) y también por Di María, que también es rosarino”, señaló Alejandra, mientras ella, toda su familia y EFE recibían cantidades industriales de espuma en espray por encima.
En la enorme fiesta rosarina tampoco faltaron gritos emblemáticos como el “Ya lo ve, ya lo ve, el que no salta es un inglés” -marcado desde el partido contra Inglaterra en el Mundial de México 1986, el anterior que ganó Argentina, con el trasfondo, además, de la guerra de las Malvinas de 1982-, un hincha caracterizado de Maradona subido a lo alto e insultos al francés Kylian Mbappé.
Rosario, donde desde hace semanas se respira alegría futbolera por las calles, no solo vio dar sus primeras patadas al balón a Messi y Di María. En esta, la tercera ciudad de Argentina, también nació otra figura de la ‘Scaloneta’, Ángel Correa. Y a una media hora en coche está el pueblo del seleccionador y ya leyenda Lionel
Scaloni.
“¡Un mundial más, Leo!”, insistió otra hincha, Luciana, mientras que su acompañante lanzó una oda a Di María: “¡Y tenemos a Angelito di María.. ¡vamos Central!”, gritó en referencia al otro gran equipo de la ciudad, Rosario Central, donde comenzó el ‘Fideo’.
Ciudad del Vaticano.- El papa Francisco pidió este domingo emprender la vía del diálogo para superar la “crisis política y social” de Perú al finalizar el Ángelus dominical en el Vaticano.
“Y recemos también por la paz en Perú, para que cesen las violencias en el país y se emprenda la vía del diálogo con el fin de superar la crisis política y social que aflige a la población”, dijo el papa ante más de 30.000 fieles reunidos en la plaza San Pedro.
Aunque Francisco olvidó pronunciar “Perú” durante la lectura del texto, la sala de prensa del Vaticano envió posteriormente una versión correcta del texto para confirmar que el pontífice hablaba del país latinoamericano.
Antes, el papa expresó su preocupación por la “situación que se ha creado en el Corredor de Lachin, en el Cáucaso Meridional”

ya que “las precarias condiciones humanitarias de las poblaciones” podrían “deteriorarse aún más durante la estación invernal”.
Perú vive una crisis institucional y social desde que el pasado 7 de diciembre su Congreso destituyera al ahora expresidente Pedro Castillo, después de que este anunciara el cierre del Parlamento peruano y la conformación de un ejecutivo de emergencia, en el que gobernaría por decreto, lo que fue interpretado mayoritariamente como un intento de golpe de Estado.
Tras la destitución, la hasta entonces vicepresidenta, Dina Boluarte, conformó un Ejecutivo al que los ciudadanos también han respondido con protestas.
Este sábado, la presidenta Boluarte descartó que vaya a renunciar y exigió al Congreso reconsiderar “la votación del adelanto de elecciones”, tras el rechazo en la víspera del proyecto del Ejecutivo
para celebrar comicios en diciembre de 2023, mientras persisten las protestas en el país, que ya dejaron al menos 23 muertos. Boluarte, quien lleva once días en el cargo desde que reemplazó al destituido expresidente Pedro Castillo, anunció además una
pronta recomposición de su gabinete de ministros para enfrentar mejor la crisis, después de que dos de sus ministros renunciaran en rechazo a las muertes.
Los manifestantes coinciden en protestar por la destitución de Castillo y en exigir el adelanto
de las elecciones y el cierre del Congreso. Otros piden también la dimisión de Boluarte y que se libere a Castillo, que está detenido acusado de rebelión desde que intentó disolver el Congreso, con el que estaba enfrentado, la semana pasada.

Miami.- La ciudad fronteriza texana de El Paso, declarada en estado de desastre, se prepara para recibir y atender a un aluvión de hasta 6.000 migrantes si el próximo miércoles deja de regir una norma que autoriza a expulsarlos de EE.UU. en determinados casos.
Según fuentes municipales citadas por la prensa local, se espera que entre 4.000 y 6.000 migrantes lleguen a la ciudad a partir del miércoles 21 de diciembre, cuando está previsto que expire el Título 42, una medida legal de carácter sanitario tomada por la Administración del presidente republicano Donald Trump (2017-2021).
El alcalde de El Paso, Oscar Leeser, anunció el sábado la declaración del estado de emergencia por siete días a contar desde ayer, 17 de diciembre, y aseveró que el Concejo Municipal la ratificará a principios de la semana que entra. Después de negarse durante semanas a tomar la medida, el alcalde dijo que cambió de parecer porque los centenares de solicitantes de asilo que han sido puestos en libertad por la patrulla fronteriza, incluyendo familias con niños, están en las calles del centro de El Paso viviendo a la intemperie a temperaturas bajo cero.
La situación va a empeorar a partir de este miércoles, agregó.
El alcalde dijo haber hablado con autoridades federales y cuando les preguntó si creían que podían manejar la situación, la respuesta que le dieron fue negativa.
“Cuando escuché que la respuesta era no, supe que teníamos que hacer algo de inmediato”, dijo Leeser.
El Título 42 es una orden de salud pública destinada a detener la propagación transfronteriza de la covid-19 que permite a los agentes fronterizos expulsar a ciertos migrantes a México.

El viernes pasado, un tribunal de apelaciones dictaminó que el Título 42 expirará el miércoles a menos que se presenten nuevos recursos.
La declaración de desastre permite solicitar recursos adicionales y apoyo del estado para aumentar el personal, los lugares de refugio y los medios de transporte para los migrantes.
Según la declaración, el personal municipal establecerá un Centro de Operaciones de Emergencia en El Paso e implementará planes para proteger la salud, la seguridad y el bienestar de los migrantes.
Mientras tanto, la Oficina de Manejo de Emergencias de EE.UU. ha estado enviando a la ciudad fronteriza con México equipos móviles para ayudar a los migrantes que están siendo liberados por la patrulla fronteriza en el centro de El Paso.
Esos equipos se enfocan en ayudar a las personas a organizar el transporte y ofrecerles refugio para protegerlos de los elementos y las bajas temperaturas.
Según el canal de El Paso KVIA, vecinos de la ciudad están
ayudando solidariamente a los migrantes que están acampados en las calles con alimentos y bebidas, mantas y ropa de abrigo e incluso atención médica a quien lo necesita.
“Llevo nueve años privada de la libertad por narcotráfico y cuando no tengo toallas uso medias, trapos o mi ropa”, cuenta una mujer recluida en la cárcel del Buen Pastor, en Bogotá.
Según el Comité Internacional de la Cruz Roja (CICR), en América Latina mujeres y adolescentes representan el 6,3 % de la población carcelaria, con servicios básicos precarios, lo que provoca que tengan su periodo en condiciones difíciles.
La Fundación Retorno a la Libertad en Colombia trabaja en las cárceles para garantizarles una situación más digna. Su coordinadora jurídica, Laura Perdomo, insiste en que el sistema penitenciario debe dotarlas con kits de aseo, pero esto no es constante.
“El Instituto Nacional Penitenciario debe darles mensualmente un paquete de diez toallas higiénicas, pero entregan el kit cada tres meses”, lamenta Perdomo, al disponer de dos toallas por mes, cuando necesitan 16.
Según el Inpec, para 2023 se proyecta la entrega de tres paquetes de toallas en el kit de aseo, que será entregado mensualmente.
A través del proyecto Periodo con Orgullo, la fundación pretende entregar toallas reutilizables, además de brindarles acompañamiento jurídico ante la dureza de vivir en una cárcel donde muchas mujeres padecen infecciones urinarias y vaginales.
“El amor propio se cae, tienen tristeza y depresión, sean culpables o no, estas mujeres tienen derechos”, enfatiza Perdomo.
LA MENSTRUACIÓN COMO ASUNTO PÚBLICO
“La salud menstrual es parte integral de los derechos a la salud sexual y reproductiva. Es un factor decisivo para la realización de los derechos humanos de las niñas y las mujeres”, manifestó durante el 50º periodo de sesiones del Consejo de Derechos Humanos la expresidenta chilena Michelle Bachelet, quien hasta agosto pasado era la Alta Comisionada para los Derechos Humanos de la ONU. Por eso Carolina Ramírez, de Princesas Menstruantes, insiste en que las políticas públicas se enfoquen en el cuidado menstrual. “Siempre son las mujeres las que cuidan a otros, pero no ejercemos el autocuidado”, comenta.
“La menstruación es un asunto público y entenderla como algo privado ha sido perjudicial”, señala Carla Fernandini de la Fundación Gente de Calle en Santiago de Chile, quien pide entender lo que viven las mujeres en situación de calle.
“En la medida en que una autoridad entienda lo que significa para una mujer o una adolescente no poder ejercer con dignidad un autocuidado, una autonomía corporal” habrá un mejor balance y una mayor igualdad, recalca por su parte Hugo González, del UNFPA.
* “Ojalá aprendamos a interiorizar el momento, que es lo que realmente nos trasciende lo más íntimo de nuestro ser, injertándonos paz y sosiego; aire del que estamos muy necesitados, los moradores actuales del planeta”.
VÍCTOR CORCOBA HERRERO - EL SIE7E corcoba@telefonica.net
Todo ser humano sueña con un mundo más equitativo y solidario, con unas condiciones de vida dignas y una armónica convivencia que active las relaciones entre las personas. Sin embargo, con demasiada frecuencia no sucede así. Por eso, el buen talante y la disponibilidad hacia las compasivas acciones, acrecienta el entusiasmo y nos llena de vida; aunque en cuantiosas fechas corramos el riesgo de ceder ante el mal, que parece triunfar en más coyunturas de las que esperamos. Justo, en este tiempo de encuentros y de brindis en favor de las sanas aspiraciones, hemos de confiamos en desvivirnos por vivir, abrazados a los vínculos e intentar ser felices. Naturalmente, pueden surgir actitudes que nos alejan o sentimientos que nos sobrepasan; pero, en cualquier caso, hay que reponerse siempre con la mejor de las expresiones.
Sea como fuere, tenemos que ser capaces de hallarnos a nosotros mismos, siendo fieles a nuestra propia identidad, fomentando sin complejos la guardia del poeta y el desprendimiento del santo nombre de Jesús niño, compartiéndolo todo con la sencillez del donante y ubicándolo comunitariamente, haciendo hogar o si quieren dándonos luz a golpe de corazón, con firmeza y suavidad. Ojalá aprendamos a interiorizar el momento, que es lo que realmente nos trasciende lo más íntimo de nuestro ser, injertándonos paz y sosiego; aire del que estamos muy necesitados, los moradores actuales del planeta.
También es natural que, aquello que tiene alma, brille por sí mismo; y así, resplandeció como jamás en el “Magníficat” una gratitud llena de humildad, señal del encuentro íntimo de María, que responde al Don de lo alto con la mística de la entrega. Indudablemente, aquí nace nuestra gran tarea, que no es otra que el espíritu conciliador entre la propia especie, toda vez que ha de germinar reconciliada consigo mismo y con la viviente creación. Ciertamente, el camino no es nada fácil. Son muchas las oscuridades, pero nuestra continuidad como linaje, se basa en otro hálito más auténtico y solidario, que sea capaz de poner amor donde habita el odio y alianzas donde reinan las hostilidades. Lo importante es sentirse respaldado humanitariamente y unidos en la diversidad de nuestras sociedades, por lo que nos incumbe además, la responsabilidad colectiva de respetar y defender nuestros distintivos principios y valores humanos, en especial la de los más vulnerables y, en particular, aquellos que aún han de estar en formación, a los que no les podemos sustraer el futuro. Hay evidencias que están ahí, que deben hacernos despertar nuestra morada interior, para poder salir de este mundo de apariencias e ilícito a más no poder, que requiere de otras vivencias, pensamientos y sentimientos. Hemos de reconocer que la humanidad anhela, sobre todo ahora, despojarse de tensiones
y tristezas para retornar a la alegría, con la quietud necesaria para huir de este mundo enfermizo y desigual, desordenado, que lleva en su culpa un aluvión de penas, a las que tenemos que hacer frente de manera conjunta. Se divulga que nos hemos mundializado, pero no hermanado, que es la gran fuerza positiva existencial. También necesitamos sentirnos libres de violencias, hambre, opresión e injusticas, y la mejor forma de garantizarlo es poniendo el amor operante en los labios de cada latido que transita. Tampoco hay otro modo de vivificarse en el gozo que, la de extender la mano para incluir, a los que no tienen aún los mismos derechos y oportunidades de realización, en el proceder de cada día.
Ciertamente, todos tenemos miserias en los rincones tenebrosos del nervio, que requieren de una tranquilidad interior más profunda, si en verdad queremos florecer hacia otro mundo más habitable, exento de la plaga de la deshumanización y del virus de la inhumanidad. Hoy millones de personas abandonan sus países cada año, con programas de migración laboral temporal, que prometen beneficios tanto para las naciones de destino como para las de origen, pero muchas veces y en demasiadas circunstancias, esos planes de empleo imponen restricciones inaceptables a los derechos humanos. Son, precisamente, estas crueles atmósferas las que nos dejan debilitado el inconfundible espíritu combativo. Por tanto, hay que reivindicar la Navidad con el abrazo permanente y el aliento a los hermanos que tienen necesidad de nuestra ayuda cariñosa. Dejemos a un lado, en consecuencia, la fiesta del despilfarro. El Dios que viene está en ese humano indefenso, en ese ser abandonado que gime y nadie seca ni sus lágrimas. Pongamos imaginación, a través del ojo del alma, para llegar a los desfavorecidos que no encuentran consuelo de parte de sus análogos. Lo edénico será acariciar con la mirada, hablar con el corazón y moverse con la mente. No hay mejor propósito, desde luego, para no desatinar el paso de su tino.del instante que vivimos, sobre todo abriendo fronteras y parando frentes inútiles. No olvidemos que es vital compartir ideas para configurar ese mundo fraterno, que ha de hacerse realidad más pronto que tarde, por nuestra propia continuidad como linaje. Las cuestiones relacionadas con ese ánimo cooperante y colaborador han de estar siempre en nuestras preocupaciones diarias. De ahí, la exigencia de recriminarnos cuando esa dimensión incondicional de entrega y apertura no exista, o se haya quedado solo en palabras. Los sueños se construyen con el corazón de cada ser humano, puesto que cada pulsación viviente es única, pero ha de estar dispuesto ese latido a conjugar el enérgico poema interminable de la existencia. No le pongamos grilletes al alba. Dejemos que amanezca para todos, pues las sombras de un mundo cerrado, donde sus moradores además se encierran entre sí, produciéndose el todo contra todos, verdaderamente nos destruye. Reprendámonos, antes de que sea demasiado tarde.
*La Reforma Electoral, Mantiene el Espíritu de la Propuesta
Electoral: MORENA
*Ante Constantes Ataques, Indispensable dar Protección a las y los Migrantes: PRI
MIGUEL BARBA -EL SIE7EEl Grupo Parlamentario de Morena celebró la aprobación de las reformas a leyes secundarias en materia política-electoral, con las cuales se mantiene el espíritu de la propuesta original del Ejecutivo federal, además que ésta no altera en lo absoluto los procedimientos legales, señaló el diputado Ignacio Mier Velazco, coordinador de la bancada.
En un comunicado, el legislador aseveró que sólo en los regímenes autoritarios hay intocables. “Nuestro país es orgullosamente demócrata, con la llegada de la Cuarta Transformación demostramos e hicimos valer la voluntad del pueblo para decidir, por lo que en esta nación no tienen cabida aquellos que se resisten a ser señalados, tocados”.
Lamentó que algunos consejeros del INE, como Lorenzo Córdova y Ciro Murayama, se aferren a los privilegios de la burocracia dorada, sueldos estratosféricos a comparación de un profesor de escuela pública.
“Ahora que en la Cámara de Diputados tocamos esos excesos, rápidamente reaccionaron, porque el mayor acierto de la reforma electoral fue precisamente atacar el bolsillo de esos empleados de la nación.
“Coincido ampliamente con lo señalado por el Presidente de México: en una democracia nadie puede ser intocable. El autoritarismo sí plantea que no se puede tocar al intocable, pero en la democracia es la voluntad del pueblo.
En el marco de la aprobación de las minutas que reforman, adicionan y derogan diversas disposiciones de la Ley General de Instituciones y Procedimientos Electorales (LGIPE), las y los integrantes de la bancada de Morena saludaron la pertinencia del Grupo Parlamentario del PVEM para reservar el artículo 12, con el fin de erradicar cualquier duda o atisbo de beneficio particular.
Mier Velazco indicó que ahora está en manos del Senado de la República aprobar la última modificación a la minuta con la que se elimina la cuestionada transferencia de votos.
El coordinador parlamentario lamentó que los partidos de oposición, en su visión conservadora, se hayan opuesto a aprobar una reforma constitucional integral que proponía reducir el presupuesto de los partidos a la mitad o alcanzar ahorros por 15 mil millones de pesos por la reducción del aparato electoral, así como la eliminación de los 200 diputados plurinominales. “Por eso vamos a seguir insistiendo en una reforma que materialice el deseo de millones de mexicanas y mexicanos: una democracia más barata y órganos electorales que no estén en manos de los partidos ni de las cúpulas del poder económico que hoy ostenta Claudio X. González”, concluyó.
En otro tema, el Grupo Parlamentario del PRI señaló que es indispensable dar protección a las y los migrantes, por lo que condenó el despojo de una caravana en Zacatecas.
La bancada exigió en un comunicado que las carreteras tengan mayor vigilancia por parte de la Secretaría de Seguridad, la Guardia Nacional y las policías estatales y municipales, en particular en los estados de Zacatecas, San Luis Potosí, Michoacán, Jalisco y Guanajuato, en donde muchos paisanos regresan a sus casas en esta temporada.
Encabezados por el coordinador Rubén Moreira
Valdez, las y los legisladores priistas condenaron la situación que enfrentó la caravana de paisanos migrantes que transitaba por una carretera zacatecana, en la que fueron despojados de sus vehículos y abandonados.
“Exigimos una mayor vigilancia en el tramo Concha del Oro-Zacatecas y en el que va de ese punto a Durango”, apuntó la bancada.
Es lamentable, una vez más, la actuación de grupos delincuenciales en Zacatecas, y que éste se haya convertido en un narco-estado.
“Observamos con preocupación la incapacidad para enfrentarlos y parar la ola de inseguridad en esa entidad”, destacó.
De igual manera, es preocupante que por las noches ya no se pueda circular por las carreteras y caminos de esas entidades y que los migrantes, que juntan recursos durante todo el año, para venir a su tierra, sean violentados por el narcotráfico.
“Por lo que consideramos indispensable darles protección, para que puedan visitar nuestro país sin miedo.
“Es urgente e impostergable el trabajo conjunto de los tres órdenes de gobierno, unir fuerzas para que los mexicanos que habitan en el país o vienen de fuera, puedan transitar con libertad y tranquilidad, porque se ha demostrado que actuar juntos funciona, como sucede en Coahuila”.
Las autoridades federales y los gobernadores deben cumplir con las expectativas de la ciudadanía y de nuestros connacionales, concluyó el grupo parlamentario.
De salida les informamos que es necesario el respeto y la seguridad a los mexicanos residentes en el extranjero que regresan a territorio nacional en las fiestas decembrinas, demandó el diputado Roberto Alejandro Segovia Hernández (PVEM).
Lo anterior, en comunicado, al exigir a las autoridades federales su apoyo para facilitar y vigilar que la migración sea ordenada, regular y confiable.
El legislador exhortó a las dependencias, entidades y órganos desconcentrados responsables, asegurar el ingreso, tránsito y salida de los connacionales residentes en el extranjero.
Asimismo, que se lleve a cabo con respeto de sus derechos, seguridad de los bienes que llevan, y donde se informe de las herramientas con las que cuentan, para denunciar actos de corrupción, extorsiones y abusos de la autoridad de los que puedan ser víctimas.
El Instituto de Mexicanos en el Exterior y la Secretaría de la Función Pública pusieron en marcha la aplicación “Denuncia Paisano”, cuyo propósito es asegurar que los viajeros migrantes que se internan a México estén protegidos, al tiempo de permitir la prevención de la corrupción y la extorsión en puntos fronterizos, dijo.
Explicó que en las acciones de prevención al Instituto Nacional de Migración (INM) y a los consulados y embajadas les corresponde apoyar a los migrantes que acudan a realizar diversos trámites y servicios de su interés, y a las autoridades de seguridad pública compete vigilar, proteger y contribuir a que la movilidad sea segura.
Ni duda cabe que la final del mundial de futbol, llevado a cabo en Qatar acaparó la atención de millones de mexicanos, quienes fueron testigos de un juego de altísimo nivel, altamente competitivo y trepidante a lo lago de los 120 minutos que éste duró.
Los futbolistas de las selecciones de Argentina y Francia demostraron, además, un esfuerzo físico y mental pocas veces visto. Su desempeño y esfuerzo has sido ejemplo de lucha paras cualquier atleta que compita en otra disciplina deportiva.
Tras 120 minutos de perseguir, tener, compartir y golpear al balón, el marcado reflejó lo que millones de personas en el mundo vimos: una perfecta concentración, disciplina en la cancha y hambre de triunfo. La emoción que nos regalaron, viene a confirmar por qué el balompié es el deporte mundial.
La final vivida ayer en Qatar quedará como ejemplo de lo que es capaz de hacer el futbol, cuando éste se juega de una manera excelsa, pulcra, perfecta y con un esfuerzo físico digno de resaltar.

Presidente de México, Andrés Manuel López Obrador, ayer al iniciar los tiempos extras de la final del mundial de futbol entre las selecciones de Francia y Argentina.
“ Voy con Argentina por el Che, por Maradona … y por su pueblo “



